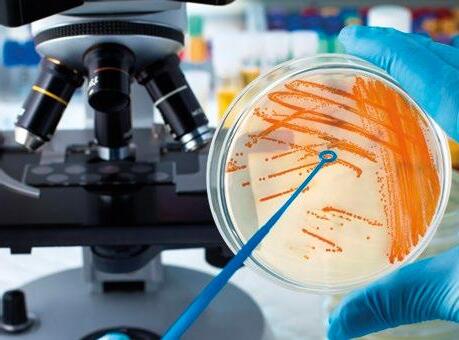

PORVAXIN ® Parvo+Ery suspensión inyectable para porcino
Composición por dosis (2 ml): Parvovirus porcino inactivado, cepa CAPM V198, S-27 ≥ 4 log2 y Erysipelothrix rhusiopathiae inactivado, serotipo 2, cepa 2-64 PR ≥ 1. Indicaciones y especies de destino: Inmunización activa de cerdas (primíparas y multíparas) para reducir los signos clínicos (lesiones cutáneas y fiebre) de la erisipela porcina causada por Erysipelothrix rhusiopathiae y para prevenir la infección transplacentaria de embriones y fetos de cerdas primíparas y multíparas causadas por parvovirus porcino. Contraindicaciones: Ninguna. Precauciones: Conservar y transportar refrigerado (entre 2ºC y 8ºC). Proteger de la luz. No congelar. Tiempo de espera: Cero días. Con prescripción veterinaria. Titular: Bioveta, a. s. Reg. Nº: 3770 ESP
En octubre asistimos a porciForum LATAM 2023 en Miami (EE.UU.). Fue el primer porciForum celebrado en América para toda la comunidad latinoamericana, desde México hasta el final de América, que comparten Argentina y Chile.
Las reuniones técnicas fueron excelentes con magníficos ponentes y con unas ponencias que giraron en torno a las cerdas hiperprolíficas y cómo debemos afrontar los diferentes retos que plantean.
El concepto de la hiperprolificidad ha venido para quedarse. En la ecuación de la productividad, cualquiera que sea la variable que elijamos para medirla, el número de unidades producidas es uno de los factores fundamentales, pero debe ir estrechamente ligado al resto de variables, covariables o modificadoras del efecto, que nos llevarán al número total de unidades vendidas. El avezado lector sabrá interpretar esta última frase. Este es nuestro reto.
He leído estos días un artículo de Enric Marco donde reflexiona sobre la necesidad de reducir la mortalidad de los lechones, tanto en fase de lactación como en destete, dado que es inasumible, aunque ahora sea económicamente viable, el mantener esas tasas de mortalidad. Si a ellas les sumamos los lechones nacidos muertos, estamos perdiendo por el camino mucho beneficio aportado por la hiperprolificidad.
Bien sea debido a la virulencia del virus causante del PRRS, bien a los problemas digestivos o a los problemas patológicos generales, la investigación para encontrar solución a estos problemas patológicos es de capital importancia y las autoridades de la Unión Europea, las empresas del sector, productores y farmacéuticas deberían aunar esfuerzos y poner todos los medios al alcance de la investigación para resolver estos problemas.
Al fin y al cabo, en la época del bienestar animal, no es ni más ni menos que eso, un problema de bienestar animal, pero también económico y social.
En Miami, haciendo pasillos y escuchando las charlas técnicas, vimos que estos problemas son globales. Los sufren y padecen tanto los cerdos, como los técnicos y propietarios de todo el mundo.
La patología que incrementa la tasa de mortalidad y reduce la cantidad de carne que podría haber en el mercado es prácticamente igual en todo el mundo. Y es que las cerdas hiperprolíficas también están en todo el mundo.
No solo afecta a la economía y al entorno social de los que estamos en este sector. Afecta a todo el mundo a través de la sostenibilidad de la producción de proteína animal para el consumo humano.
Debemos de ser más conscientes de esta realidad. Sin caer en fanatismos ni en alarmismos, debemos aprender leyendo informes que nos expliquen claramente cuáles son las métricas que debemos usar para intentar disminuir la huella ambiental de nuestras producciones.
Dentro de la llamada al incremento en investigación y desarrollo que hacía antes, no quiero olvidarme de las empresas productoras de materias primas para la alimentación animal y las empresas de investigación en aditivos alimentarios para que generen productos de alto valor añadido de forma que nuestros cerdos sean más eficientes y sostenibles. Aquí y todo el mundo, porque nuestro sector también es global.

PUBLICIDAD
Laura Muñoz
+34 629 42 25 52
Luis Carrasco
+34 605 09 05 13
REDACCIÓN
Daniela Morales
Óscar Cáceres
Osmayra Cabrera
COLABORADORES
Alberto Morillo Alujas
Laura Pérez
Jordi Baliellas
Vicens Enrique-Tarancón
Fernando Laguna
ADMINISTRACIÓN
Mercè Soler
Barcelona
España
Tel: +34 93 115 44 15 info@agrinews.es
www.porcinews.com
Precio de suscripción anual: España 30€
Extranjero 90€
DIRIGIDA
Depósito Legal Porcinews B17989-2015
ISSN (Revista impresa) 2696-8029
ISSN (Revista digital) 2696-8037
Revista Trimestral
La dirección de la revista no se hace responsable de las opiniones de los autores.
Todos los derechos reservados.

4/7
¿Nos estresa Rosalía?

Laura Pérez Sala
Veterinaria especialista en producción porcina & Personal Coach
La presencia de cepas altamente patógenas del vPRRS genera en los ganaderos y técnicos un estrés sostenido en el tiempo. ¿Qué nos recomiendan los expertos para hacerle frente?
8/12
BehavePro®: Tu aliado para reducir la agresividad y el estrés en porcino
Irene María Alonso, Encarnación Jimenez y Sandra Olivera
Departamento Técnico - I+D de Cargill Nutrición Animal, Mequinenza - España
14/22
Influencia mutua de la microbiota del lechón y los patógenos víricos - Las infecciones víricas afectan a la microbiota del lechón
Alberto Morillo Alujas
Dr. en Veterinaria y Consultor de Tests & Trials S.L.U
La microbiota del lechón puede verse modificada por las infecciones víricas, lo que debe tenerse en cuenta al diseñar planes de control y tratamiento.
24/28
Alimentación sin suplementación de fosfato inorgánico desde el destete hasta el sacrificio: contribución a una producción porcina más sostenible
David Torrallardona1, Peter Ader2 y Dieter Feuerstein2
1IRTA, Mas Bové, Constantí, España
2BASF SE, Nutrición animal, Ludwigshafen, Alemania
30/38
Impacto de las micotoxinas en la reproducción porcina
A. Quiles
PHD Universidad de Murcia
Las micotoxinas originan importantes pérdidas económicas en el sector porcino y, concretamente, debido a sus efectos sobre la reproducción.
40/47
Granja Solallong, una granja de Diamante
Óscar Cáceres
Redactor en agriNews
48/50
Objetivo primerizas: Boehringer Ingelheim pone en valor la figura de las cerdas primerizas para optimizar productividad y rendimiento
Servicio Técnico de Boehringer Ingelheim Animal Health España
52/54
Decálogo de buenas prácticas para la prevención y control del PRRS
Inés Ruedas-Torres1, Jaime Gómez-Laguna1, Guillermo Ramis2, Cinta Prieto3, Enric Mateu4, Gerard Martín-Valls4, Ivan Díaz5, Carles Vilalta5, Francisco Javier Martínez-Lobo6, Lorenzo Fraile6 y Jordi Baliellas7,8
1Universidad de Córdoba
2Universidad de Murcia
3Universidad Complutense de Madrid
4Universitat Autònoma de Barcelona
5CRESA-IRTA
6Universitat de Lleida
7Grup de Sanejament porcí de Lleida
8Interporc
Los pilares básicos en la prevención y el control del PRRS son la Bioseguridad, el Manejo, la Monitorización y la Inmunización.
56/60
Últimos avances en la mejora genética porcina: mejora de la rusticidad y longevidad en líneas PIC®
Servicios Genéticos PIC®
64/72
Diagnóstico de las principales patologías infecciosas en lechones lactantes


Desirée Martín Jurado y Mireya Melero Pérez Exopol S.L.
En este artículo abordamos el muestreo y diagnóstico laboratorial a realizar en lechones en función del proceso patológico.
74/81
Un acercamiento al circovirus porcino tipo 3 (PCV-3)


Elena Goyena Salgado1,2, Emilio José Ruiz Fernández2, Manuel Guerra Rico
Manuel Toledo Castillo3, José Manuel
Pinto Carrasco4 y Rocío Garcia Espejo
1Doctora en Medicina Veterinaria por la Universidad de Murcia.
2Veterinario de producción, Agropecuaria Casas Nuevas.
3Veterinario jefe de producción, Agropecuaria Casas Nuevas.
4Ingeniero Agrónomo, SAT Hnos. Chico.
5Asesora técnica veterinaria, Boehringer Ingelheim Animal Health España
En este artículo se expone un caso clínico que se presentó en una explotación de 900 cerdas reproductoras con manejo en bandas semanales.
82/88
Acidificación de deyecciones ganaderas en balsas de almacenamiento en clima mediterráneo: Proyecto demostrativo ACIDEMO

90/93
Míriam Cerrillo, Miguel Moreno, Laura Burgos, Joan Noguerol y August Bonmatí
IRTA, Sostenibilidad en Biosistemas, Caldes de Montbui, Barcelona
El proyecto ACIDEMO tiene como objetivo determinar el efecto de la acidificación de purines como medida para minimizar las emisiones de gases.
La granja inteligente I-Farms de New Farms: Revolucionando la cría de cerdos de engorde
94/99
Logotipo raza autóctona 100% - Garantía de calidad diferenciada del Porco Celta
Mª Cruz Castro Pumares
Veterinaria – Asociación de Criadores de la Raza Porcina Celta (ASOPORCEL)
El Logotipo Raza Autóctona 100% pone en valor todas las bondades de los productos del Porco Celta en el etiquetado que llega a manos del consumidor final.
100/104
La importancia de mantener la salud hepática en las cerdas reproductoras
Manuel Guerra y Emilio Ruiz
Departamento de Producciones de Agropecuaria Casas Nuevas
Agradecemos a nuestros anunciantes por hacer posible la publicación de esta revista: AAF, Agrovision, Axiom, Basf Animal Nutrition, Bbzix, Bioplagen, Boehringer Ingelheim Animal Health, Cargill, Datamars Livestock, DFBlueFarm, Lidervet, Liptosa, New Farms, OPP Group, PIC, Prebiotec, Produmix - Igusol, Qualivet y Vetia Animal Health.

Laura Pérez Sala Veterinaria especialista en producción porcina & Personal Coach
La situación sanitaria de las granjas porcinas de nuestro país ha sufrido un fuerte revés en los últimos 3-4 años. La presencia de cepas altamente patógenas del virus del PRRS (vPRRS) han provocado importantes pérdidas productivas y económicas en la mayoría de las empresas.
La aparición de estas cepas ha coincidido con otros retos importantes de la industria, como la antibióticos y la prohibición de óxido de zinc en los piensos de los lechones.

Dejando aparte el impacto económico de Rosalía, una cuestión que no podemos olvidar es el impacto emocional en los trabajadores.
Las cepas patógenas del vPRRS causan brotes de alta gravedad caracterizados por elevados porcentajes de abortos y mortalidades altísimas en lechones de todas las edades e, incluso, de cerdas reproductoras.

Para más inri, la estabilización de las granjas se alcanza de media a los 6 meses post-brote, con una alta probabilidad de reinfección al año debido a la alta y rápida capacidad mutante del virus. mortalidad.
Esta situación provoca en los ganaderos y técnicos un estado de estrés sostenido en el tiempo.

Es normal vivir situaciones de estrés en el día a día, incluso es útil tener un cierto nivel de estrés para alcanzar un rendimiento óptimo en determinadas situaciones como, por ejemplo, un pico de trabajo, una competición deportiva o una negociación importante. Pero nivel de estrés excesivamente elevado y mantenido en el tiempo es contraproducente.
“dosis” de estrés es exagerada con respecto a la situación estresante, más que ayudarnos nos bloquea (por ejemplo, el pánico escénico) y, si el estrés se mantiene prolongada en el tiempo y estamos en un estado de alerta continua, también trae consecuencias negativas físicas y psicológicas.

En momentos de estrés, las funciones anabólicas de recuperación, renovación y creación de tejidos se detienen, y el organismo cambia a un metabolismo catabólico para hacer frente a la situación de emergencia. Este complejo sistema de alarma natural también se comunica con las regiones del cerebro que controlan el estado de ánimo, la motivación y el miedo.
Normalmente, las células de nuestro cuerpo destinan la mayor parte de su energía a actividades metabólicas, renovando y formando nuevos tejidos.
Sin embargo, cuando se produce una situación de alarma que interpretamos como una amenaza, es decir, una situación de estrés, nuestro cerebro ordena a las glándulas adrenales que liberen cortisol que se encarga de regular las concentraciones de glucosa en el cuerpo para así proporcionar a nuestros músculos energía adicional.
Normalmente, cuando la situación de estrés es puntual, una vez superada, los niveles hormonales y procesos fisiológicos vuelven a la normalidad.
En cambio, cuando el estrés es prolongado, los niveles de cortisol mantenidos en el tiempo provocan síntomas físicos y psíquicos.
Esta técnica de supervivencia heredada de nuestros ancestros, como buenas presas, nos sirve para tener los músculos preparados para la huida. Síntomas
Síntomaspsicológicos
Decaimientoyapatía
CefaleasAgotamientofísico/cansancio
Hipertensión
Calambres
Cambiosenelapetito(aumentoo disminución)
PérdidaProblemasdigestivosygastrointestinales
Insomnio
Cuando nos encontramos inmersos en pleno brote, es habitual sentir una gran frustración. “Dan ganas de cerrar la puerta y largarse” es una de las frases más repetidas. Y es que la frustración a veces tiende a activar respuestas impulsivas, como responder de forma enojada, y es ahí donde se generan consecuencias negativas.
Los expertos recomiendan lo siguiente:
Dice el refrán que “las penas compartidas pesan menos” y es cierto que no sentirse solo en situaciones vulnerables ayuda a soportarlo mejor.
Conversar, debatir, ver aspectos de mejora con compañeros, compartir ideas y soluciones, levanta el ánimo y estimula el aprendizaje.
Evitar sentimientos de culpabilidad
En situaciones de estrés, la mente genera pensamientos automáticos, generalmente destructivos, exagerados e irracionales.
Hay que aprender a aparcarlos, racionalizarlos y darles la importancia justa.
En el caso de la entrada de Rosalía a una granja, detectar el posible error (por ejemplo, de bioseguridad) nos tiene que servir para implementar mejoras, nunca para buscar culpables.
Pensar constantemente en qué nos deparará el futuro y si seremos capaces de salir de la situación provoca mucho sufrimiento y nos bloquea.
Si bien, el deporte incrementa momentáneamente los niveles de cortisol, una vez finalizado el entrenamiento éste vuelve a su nivel habitual y generamos además endorfinas.
La actividad física regular combinada con una buena alimentación ayuda a equilibrar nuestro sistema hormonal y nos permiten descansar mejor.
“Aquellos que creen que no tienen tiempo para hacer ejercicio, tarde o temprano tienen que buscar tiempo para estar enfermos”.
- Edward StanleyCuando nos marcamos una meta o un objetivo, nos activamos y dejamos de lado el desánimo. Para ello, es necesario marcarse objetivos alcanzables y que no sean excesivamente ambiciosos.
Por ejemplo, sabemos que actualmente no hay un tratamiento definitivo para el PRRS, ahora mismo no está en nuestras manos “curarlo”. Pero sí que podemos implementar estrategias preventivas y de bioseguridad que disminuyan la diseminación y la prevalencia.

Anticipar escenarios y soluciones crea expectativas reales.
Otra recomendación es hacer una actividad que ayude a descargar la emoción desagradable y ayude a conectar con una emoción positiva. Lejos de distraernos, lo que conseguimos es gestionar las emociones, disminuyendo la intensidad de las negativas a favor de las positivas, y evitando entrar en bucles destructivos.

Este es el gran antídoto contra el estrés, siendo la práctica de técnicas de relajación altamente recomendable. Existen muchísimas técnicas y en internet se encuentran disponibles relajaciones guiadas, meditaciones, ejercicios de mindfulness, etc. Incluso existen aplicaciones de móvil que ayudan a entrenarnos en estas técnicas en nuestra casa sin necesidad de acudir a un centro.
Para escépticos o inquietos (como yo), podéis empezar con sesiones de tan solo 5 minutos, en algún lugar tranquilo e íntimo, centrados en la respiración consciente. Con el tiempo, el cuerpo se acostumbra a estos períodos de reseteado e incluso pide más.
También es posible practicar la meditación paseando, tomando consciencia del cuerpo y la respiración, sin teléfonos ni distracciones externas.
Ya hemos visto que una de las consecuencias del estrés es el cambio del apetito, siendo posible la falta de él o el consumo compulsivo.
Lo fundamental es basar nuestra alimentación en alimentos naturales y evitar lo procesado, disfrutando de alimentos ricos en vitamina B y triptófano, proteínas de alta calidad, ácidos grasos esenciales, carbohidratos complejos, vitaminas y minerales, limitando a su vez el consumo de café, alcohol y azúcar.
En cuanto al sueño, evitar pantallas antes de acostarnos y seguir un horario regular nos ayudarán a dormir mejor. ¿Nos
El sentido del humor es lo que nos diferencia del resto de especies. Nos provoca placer, bienestar y crea vínculos con quien compartimos risas.
Realizar actividades con amigos, familia o compañeros, nos relajará y nos ayudará a recuperar el bienestar emocional.
Buscar asesoramiento profesional que nos enseñe a desarrollar estrategias específicas para afrontar el estrés puede ser de gran utilidad de cara a afrontar los retos del día a día de una granja porcina.



Irene María Alonso, Encarnación Jiménez y Sandra Olivera
Departamento Técnico - I+D de Cargill
Nutrición Animal, Mequinenza - España
En diferentes épocas, algunas ya datadas en el inicio de los años 60, autores e investigadores como Harrison, Fraiser, Mellor, Broom o Dawkins han traído hasta nuestros días la preocupación por el Bienestar de nuestros animales de granja, siendo las principales conclusiones de sus estudios consideradas y materializadas en la actualidad a través de las normativas desarrolladas en el ámbito europeo.



El abordaje del Bienestar Animal en el momento actual debería considerarse desde la última modelización publicada por Mellor (2017), “Modelo de los Cinco Dominios”, que atiende no solo a los elementos de los ámbitos de la alimentación, el confort, la salud y el comportamiento, sino que trae el quinto ámbito, el de LAS EMOCIONES, resultado de la medición de los 4 anteriores, permitiendo así el uso de protocolos de evaluación del Bienestar Animal guiados y basados en el estudio científico de los indicadores más adecuados.
La falta de un adecuado Bienestar Animal por aparición de problemas relacionados con el estrés y la agresividad en nuestras explotaciones porcinas raramente está vinculado a una única variable, sino que frecuentemente conviven circunstancias en las que los factores de riesgo son múltiples:
Estatus sanitario
Características genéticas
Manejo en las cargas y transporte
Confort físico
Confort térmico
El abordaje de la correcta evaluación del Bienestar Animal debe tener un enfoque multidimensional en el que no solo prime la evaluación de la salud física, sino que las emociones y el comportamiento de los animales también sean tenidos en cuenta.

En la producción porcina es habitual la práctica de la mezcla de animales que no han tenido contacto previo o la “desestabilización” de grupos, rompiendo así la ordenación social original de la jerarquía, dando lugar a una nueva estructura social basada en la relación de dominancia/subordinación del animal.
Esta situación puede dar lugar a un aumento del estrés y agresividad entre los animales, dándose un incremento de peleas y lesiones.
En un estudio realizado recientemente en el Centro de Investigación de Cargill (España), la incidencia de lesiones en piel del lechón aumentó 26 horas después del mezclado de animales y se redujo a los 4 días, alcanzando valores similares a los de antes de la reagrupación (Gráfica 1).
BehavePro® es un suplemento nutricional basado en una combinación de extractos vegetales cuidadosamente seleccionados que ayudan a reducir el estrés causado por factores externos y/o intrínsecos y, por tanto, reducir la agresión.
Como resultado se observó:
Mayor número de lechones inactivos (Gráfica 2).
Menor incidencia de lesiones en piel con el uso de BehavePro® (Gráfica 3), un efecto que fue más evidente inmediatamente después de la mezcla.
Reducción del consumo de agua del lechón, pero sin impacto alguno sobre el consumo del pienso (Tabla 1).
En este artículo abordaremos cómo reducir el estrés y la agresividad usando BehavePro® en tres situaciones críticas durante la crianza del lechón.
Estudio 1 – Reducción del estrés tras el mezclado
En este primer estudio se evaluó la agresividad entre lechones una vez que fueron mezclados con otros no hermanados y de peso similar (alrededor de 15,8 kg) al final de transición.
Un total de 144 lechones repartidos en corralinas de 12 lechones cada una y asignados a dos grupos:
Grupo control
Grupo BehavePro®
El grupo tratamiento tuvo libre acceso a BehavePro®, en forma líquida desde los 32 hasta los 39 días postdestete, y al tercer día tras la
*El día 0 fue el día que se suministró BehavePro®. El día 3 de prueba corresponde al día en el que se mezclaron los lechones de peso similar (50:50) y el día 7 fue el día en el que se retiró BehavePro®
Gráfica 2. Proporción de lechones inactivos*.
Control BehavePro®

*Los lechones fueron clasificados según el número de lesiones en piel: 0 = < 4 heridas frescas; 1 = entre 5 y 10 heridas; y 2 = > 10 heridas frescas.
Gráfica 3. Incidencia en el número de lesiones en piel tras el mezclado de lechones*.

Otro factor del estrés al que puede verse sometido un lechón es cualquier tipo de transporte que implique un proceso de carga y descarga de un camión.
A este respecto, se realizó una experiencia de campo con lechones en el momento del destete y su transporte posterior a matadero.
Esta prueba se llevó a cabo en un contexto muy específico de un mercado de calidad y local, como es la producción de “Marca de Garantía de Cochinillo de Segovia” en la que los lechones fueron sacrificados con un peso a la canal de 5,8 kg.
En esta producción de calidad, se busca un animal que no tenga marcas o lesiones en la piel que puedan ser motivo de descarte para consumo en el momento del asado.
Un total de 32 camadas de cerdas fueron utilizadas en este estudio, de las cuales, a la mitad se les suministró BehavePro® vía agua de bebida desde el nacimiento hasta el momento del sacrificio.
Los resultados de este estudio revelaron una reducción del 35,5% en el número de lesiones en la canal al administrar BehavePro® (Gráfica 4).
Estándar N =179 lechones
P= 0,001
BehavePro® L N =16 8 lechones
Gráfica 4. Comparativa del número medio de lesiones en piel por lechón al sacrificio.
También se midió el color de la carne en fresco y en asado por colorímetro Minolta y por panel de color, ya que éste refleja un mayor Bienestar Animal y una mejor calidad de carne.
Otros parámetros interesantes observados fueron el acortamiento del periodo de lactancia de los lechones en 2,5 días para alcanzar el peso al sacrificio (P=0,008) y la reducción de la mortalidad perinatal en un 3,64% con el uso de BehavePro®.
Estos resultados dan pie al diseño de nuevos ensayos de campo para comprobar si el producto ayuda a reducir las necesidades de mantenimiento y mejora la ganancia de peso por tener menor gasto metabólico al estar más relajados.

La caudofagia es otro evento de agresividad muy habitual entre lechones jóvenes, con un patrón de aparición totalmente al azar. Los principales factores de riesgo para su aparición son, entre otros (FAWEC, 2014):
Falta de material de enriquecimiento
Suelos de cemento
Mala ventilación
Densidades altas y grupos sociales
Salud inadecuada
En este tercer estudio, se evaluó el efecto de la inclusión de BehavePro® en su forma sólida en lechones con cola intacta.
Un total de 480 lechones de 26-65 días de edad, repartidos en corralinas de 12 animales cada una, fueron asignados a dos grupos diferentes:
Grupo control
Grupo BehavePro®
Todos los individuos estaban con una densidad adecuada, equipada con material de enriquecimiento (cadenas, pelotas y paja suministrada dos veces al día). En caso de brote, se aumentaba el enriquecimiento ambiental con palos de madera, cuerdas, etc.
Se estudió el grado de severidad de lesiones en la cola dos veces a la semana, desde el día 0 al 40 de la prueba. La severidad de la lesión en la cola fue clasificada según los siguientes grados:
0 = sin lesiones
1 = superficial
2 = área pequeña
3 = área grande
Si bien, se observó un incremento en el grado de severidad de lesión de la cola con el crecimiento de los lechones, ésta fue menor en el caso del grupo BehavePro® (Gráfica 5).
Gráfica 5. Evolución del grado de severidad de las lesiones de la cola.
En estos trabajos hemos visto cómo la utilización de BehavePro®, bien en su presentación sólida o en la líquida, ayuda a reducir el estrés en las condiciones habituales que los animales más jóvenes de la producción porcina tienen que encarar.
Minimiza los niveles de estrés entre los lechones, favoreciendo así la reducción de agresiones debidas a peleas, mordeduras de cola, mezclado de animales, transporte, etc. sin alterar el patrón de consumo de pienso.
BehavePro® es una herramienta para ayudar a los cerdos a sobrellevar las situaciones estresantes que puedan encontrarse y así reducir la incidencia de la agresividad que tanto menoscaba la producción y el Bienestar de los animales.
Los estudios han sido conducidos gracias al proyecto “Welfare+” con IDI- 20210217 en los años 2020-2022 con financiación del Centro para el desarrollo Tecnológico Industrial (CDTI) del Ministerio de Ciencias e Innovación.
BehavePro® - Tu aliado para reducir la agresividad y el estrés en porcino DESCÁRGALO EN PDF


En el artículo anterior vimos cómo la microbiota que el lechón tiene antes de padecer una infección es crucial en el desarrollo de la enfermedad, concretamente en una infección por el virus PRRS (PRRSv) y en este vamos a ver cómo se modifica la microbiota durante y después de una infección por PRRSv.


Recordando el artículo anterior, vimos el trabajo de Ober et al. (2017) en el que estudiaban la microbiota de los lechones con mayor o menor crecimiento diario tras una coinfección con PRRSv y con Circovirus tipo 2 (PCV-2).
Cuando se analizaron los resultados de las muestras fecales de ambos grupos de lechones (con mayor y menor crecimiento) se observó un aumento en la proporción de especies de Firmicutes:Bacteroidetes en la microbiota de los cerdos de alto crecimiento (5,6 en comparación con 4,2 para el grupo de bajo crecimiento, p = 0,05).
Los autores señalaron que se ha descrito que los cerdos obesos tienen menos miembros del filo Bacteroidetes en comparación con los cerdos magros (Guo et al., 2008) y tienen una correlación positiva entre el aumento de peso y el filo Firmicutes (Pedersen et al., 2013).


En el estudio de Nierderwerder (2016), la diversidad microbiana antes de la infección era menor en los lechones de menor ganancia media diaria (GMD) demostrando que la diversidad y la composición del microbioma antes de la infección influyen en el aumento de peso después de la coinfección por PRRSv y PCV-2.
Argüello et al. (2021) demostraron que la infección por PRRSv afecta a la microbiota y, además, esta afectación depende de la virulencia de la cepa con la que los lechones han sido infectados. En su estudio hicieron un seguimiento de los lechones hasta 13 días post-inoculación (dpi) con:
La cepa Lena (alta virulencia).
La cepa PRRS_3249 (baja virulencia). Los resultados en cuanto a la microbiota (Gráfica 1 y 2) fueron que los lechones infectados tuvieron más diversidad microbiana a partir del 6o día dpi, estando más afectados los lechones que se infectaron con la cepa Lena.

En la Gráfica 1 (a) se muestra la diversidad beta estimada mediante la distancia de Bray-Curtis1 y mediante escalamiento multidimensional no métrico2 de las muestras en cada momento de muestreo según el grupo experimental.
Puede apreciarse que a medida que pasan los días post-inoculación, del día 1 dpi al día 13 dpi, los grupos experimentales (control, infectados con la cepa Lena e infectados con la cepa PRRS_3249) se separan cada vez más indicando que la microbiota se va diferenciando entre los grupos.
En la Gráfica 1 (b-d) se muestran los índices de diversidad alfa con la métrica Chao13, Shannon4 y Simpson5, respectivamente.
Estas métricas de diversidad alfa y beta (ver el pie de página), y su análisis mediante métodos estadísticos multivariantes, mostraron la influencia de la virulencia de la cepa PRRSv en la composición de la microbiota.
Ambas métricas de diversidad se vieron afectadas por la infección PRRSv, especialmente a partir del día 6 dpi que es cuando se observó el pico de viremia y los signos clínicos fueron más graves.
Al finalizar el estudio en el día 13 dpi los índices de Shannon y Chao difirieron significativamente entre las categorías de grupos experimentales (p < 0,01 y p < 0,01 respectivamente; Gráfica 1 (b) y (c).
Grupo Experimental Control PRRS_3249

Gráfica 1. Análisis de diversidad en muestras de heces de cerdos infectados con PRRSv (Argüello et al., 2021).
1La diversidad beta mediante la distancia de Bray-Curtis es una medida utilizada en ecología y análisis de datos que cuantifica la similitud o diferencia entre dos conjuntos de datos, como comunidades biológicas en diferentes lugares o momentos. Se basa en la composición relativa de especies o elementos en las muestras, no en su abundancia absoluta, lo que la hace resistente a variaciones en la abundancia. Se calcula comparando las diferencias en la composición relativa compartida entre las muestras, donde 0 indica igual composición y 1 indica composición completamente diferente.
2La sigla "NMDS" en un análisis de diversidad fecal con distancia de Bray-Curtis significa "Escalamiento Multidimensional No Métrico". Es una técnica usada en ecología y biología para visualizar diferencias entre muestras en función de su composición. En el análisis de diversidad fecal, NMDS ayuda a representar gráficamente las diferencias en la composición microbiana entre muestras de heces usando la distancia de Bray-Curtis. Esto crea una representación en dos o tres dimensiones donde muestras más similares en composición están más cerca, facilitando la interpretación de la diversidad fecal.
3La métrica Chao1 en el estudio de la diversidad alfa es una herramienta usada en ecología y biología para estimar la riqueza de especies o elementos en una comunidad. Considera tanto especies comunes como raras
y se basa en las especies únicas y las compartidas entre muestras. Utiliza la abundancia de especies raras para estimar la riqueza total de la población. Chao1 es útil cuando no se pueden capturar todas las especies en una muestra y se usa para comparar la riqueza en diferentes comunidades.
4La métrica de diversidad Shannon mide la diversidad de especies en una comunidad considerando tanto la cantidad de especies como su distribución relativa. Un valor mayor indica una mayor diversidad y equidad en la comunidad. Se utiliza en ecología y biología para comparar la diversidad entre sitios o comunidades y evaluar la salud y estructura de los ecosistemas, así como los cambios en la biodiversidad a lo largo del tiempo.
5La métrica de diversidad de Simpson evalúa la diversidad de especies en una comunidad, centrándose en la dominancia de especies. Su valor varía de 0 a 1, donde cerca de 1 indica mayor equidad y diversidad, mientras que 0 significa una comunidad dominada por una sola especie. Se usa para destacar la importancia de las especies dominantes y se complementa con otros índices de diversidad, como el de Shannon, para comprender mejor la diversidad en un ecosistema o conjunto de datos.
10% de descuento en lectores


Este mes de noviembre, por la compra de +100 crotales electrónicos de porcino, consigues un 10% de descuento en lectores de ganadería.
Lee el código QR y rellena el formulario para conseguir la oferta





No te quedes sin esta oportunidad
Promoción disponble sólo hasta el 30/11/2023.



El microbioma intestinal puede desempeñar un papel positivo o negativo en el desarrollo y mantenimiento de la inmunidad del hospedador, o bien sus propiedades patogénicas oportunistas pueden causar inflamación sistémica.
de coordenadas principales (PCoA), lo que indica que el microbioma intestinal puede estar asociado al desarrollo de la enfermedad, desconociéndose los mecanismos involucrados.
Las bacterias productoras de SCFA disminuyeron de manera significativa en el grupo de lechones infectados y en las diferentes fases de la enfermedad.
6El PCoA (Principal Coordinate Analysis) a veces llamado Análisis de Coordenadas Principales, se utiliza específicamente para analizar similitudes o diferencias entre muestras o puntos en un espacio multidimensional. Toma una matriz de distancias o similitudes (siendo esto lo que lo diferencia de un PCA que toma correlaciones) entre las muestras y encuentra una representación en un espacio de menor dimensión que mejor conserve esas distancias o similitudes.
Los SCFA son principalmente producidos por miembros de los filos Firmicutes y Bacteroidetes que metabolizan los polisacáridos no digestibles.
Estos compuestos afectan directamente a la diferenciación de las células T en células T efectoras, como las células Th1 y Th17, así como a las células T reguladoras (Treg) productoras de interleucina 10 (IL-10) y, además, poseen propiedades antiinflamatorias.
El butirato (un SCFA, la principal fuente de energía para las células epiteliales del colon) inhibe la expresión de ARNm de citoquinas proinflamatorias en la mucosa pudiendo:
Alterar la expresión génica.
Inhibir la proliferación celular.
Inducir la diferenciación o apoptosis celular.
Esto explica sus propiedades antiinflamatorias y antitumorales, siendo probable que una reducción de las poblaciones microbianas productoras de butirato y otros SCFA esté asociada a anomalías en el sistema inmunitario del hospedador.

En la Gráfica 2 se observan las diferencias en la microbiota en un análisis PCoA de las muestras de los lechones infectados o no, mientras que en la Gráfica 3 se muestra el mismo tipo de análisis (PCoA) donde se distinguen las diferencias en la microbiota de las diferentes fases de la PPA (de Ko et al., 2023).

Gráfica 2. Análisis de coordenadas principales de los lechones infectados con el vPPA y los cerdos usados como controles negativos (Ko et al., 2023)

vPPA Controles negativos



Antes de la infección y controles negativos
Fase primaria de la enfermedad (0-2 días)
Fase clínica (3-7 días)
Fase terminal

1er PC (47,900%)
Gráfica 3. Análisis de coordenadas principales de la microbiota de los lechones infectados por el virus PPA en las diferentes fases de la enfermedad (Ko et al., 2023).
Uno de los resultados más importantes de este estudio es el cambio producido en el microbioma en la fase primaria de la enfermedad.
La riqueza bacteriana disminuyó significativamente en esta fase primaria de la infección por PPA, lo que podría deberse a los efectos del virus directamente sobre el microbioma, aunque no pueden descartarse por completo los efectos ambientales.
En los 2 o 3 días posteriores a la infección se detectó el vPPA en la sangre y unos días más tarde se observaron signos clínicos, incluyendo fiebre.
El vPPA en sí mismo y/o las células del sistema inmunitario afectadas que llegan al intestino a través de la circulación sanguínea pueden causar cambios significativos en el ecosistema microbiano intestinal antes de que aparezcan los síntomas clínicos en el hospedador.

Los autores remarcan que esta es la primera evidencia de que un virus puede acambiar el microbioma intestinal durante el período de incubación de la enfermedad.

El microbioma alterado resultante de la infección por vPPA es similar al observado en infecciones causadas por PRRSv en el estudio de Argüello et al. (2021) y el virus del síndrome de fiebre severa con trombocitopenia que afecta al hombre.
El microbioma afectado por estos virus compartió varias características, como el aumento en la abundancia de Proteobacteria y Spirochaetes, pero también la disminución de las familias productoras de SCFA, Ruminococcaceae y Lachnospiraceae.
Estos pueden ser los principales cambios en los que el microbioma intestinal de un cerdo se ve afectado por virus que infectan a las células inmunológicas.
Se ha observado también que, en los intestinos de cerdos afectados por virus entéricos, como el virus de la epidemia de diarrea porcina
(PEDv):
Aumentaron las poblaciones de Escherichia-Shigella, Enterococcus, Fusobacterium y Veillonella.
Disminuyeron las poblaciones de Bacteroidetes, como Bacteroides y Prevotella
El microbioma puede ser controlado según el mecanismo que el virus utiliza para su infección y proliferación. Estos hallazgos pueden ser útiles a la hora de diseñar planes estratégicos de intervención en el control y tratamiento de lechones infectados por estos virus.
 DESCARGAR BIBLIOGRAFÍA
DESCARGAR BIBLIOGRAFÍA

Todos dicen lo mismo, nosotros lo demostramos
Tenemos un programa de pienso y agua para eliminar el óxido de zinc sin tener diarreas





PROGRAMA
Estudio realizado por Test & Trials
COLIZIX®
PREMEZCLA DE ADITIVOS (SIN ZINC NI COBRE)

TRATAMIENTO DE AGUA

300
agua

1IRTA, Mas Bové, Constantí, España
2BASF SE, Nutrición animal, Ludwigshafen, Alemania

Dasociados y las interrupciones parciales en la cadena de suministro sustitución de fosfatos minerales por fitasas microbianas en la alimentación animal ha vuelto a adquirir gran relevancia económica.
Esto ha intensificado los esfuerzos para reducir el uso de fosfatos en la producción animal.

utilización del propio fósforo (P) de los ingredientes de origen vegetal que se encuentra en forma de fitatos.




En un estudio de crecimiento de cerdos desde el destete hasta el sacrificio se evaluaron los efectos de la alimentación con pienso convencional con fósforo mineral o con piensos alternativos sin fosfatos minerales y suplementados con fitasa.
72 lechones recién destetados ([Large White x Landrace] x Pietrain); 36 machos enteros y 36 hembras (7,8 ± 0,37 kg de peso corporal y 26 días de edad) fueron distribuidos aleatoriamente por sexo y peso entre las 3 variantes de alimentación (Tabla 1).
Fósforo mineral
Sin fitasa


A. Pienso convencional
Digestibilidad de fósforo y calcio
Sin fósforo mineral
Con fitasa


B. Pienso alternativo 1

Fueron alimentados con pienso convencional con fósforo mineral o dos piensos alternativos sin fosfatos minerales suplementados simultáneamente con fitasa: una alternativa se formuló teniendo en cuenta únicamente el efecto de la fitasa sobre la digestibilidad del fósforo (P) y el calcio (Ca), y la otra

Digestibilidad de fósforo, calcio, aminoácidos, proteina y energia
Sin fósforo mineral
Con fitasa


C. Pienso alternativo 2
Tratamientos
Alimentación con fosfato monocálcico (MCP); sin fitasa; Nutrientes según FEDNA, 2013
Alimento libre de fosfato, adición de fitasa microbiana1, nutrientes según FEDNA 2013
Alimento libre de fosfato, adición de fitasa microbiana1, como B pero reducido en nutrientes
Mioinositol-hexakisfosfato beta-fosfohidrolasa (6-fitasa, EC 3.1.3.26) producida por Aspergillus niger (EU-No 4a27).
Configuración experimental.
Fitasa (FTU/kg) - 3.000 3.000 - 2.000 2.000
Los animales se alojaron en corrales de dos durante la fase de transición e individualmente durante la fase de engorde. Cada tratamiento consistió en 24 animales.
El agua y los piensos granulados se ofrecieron a voluntad en las 5 fases de alimentación del ensayo (Tabla 2a-d).
Los lechones destetados se pesaron individualmente al comienzo del experimento (día 0), al final de la fase de transición (día 41) y al final del engorde (día 138).
El alimento consumido en cada período entre intervalos de pesaje fue registrado para cada corral.
La ganancia de peso media diaria, el consumo de alimento y el índice de conversión de alimento se calcularon a partir de los datos registrados.
Los animales fueron sacrificados al final del experimento. La pezuña delantera izquierda fue muestreada removida y se guardó congelada hasta la posterior determinación de peso seco y contenido de cenizas del correspondiente tercer metacarpiano (Os metacarpale III).
*Proporciona por kg de alimento: Vitamina A (E672) 10000 UI; Vitamina D3 (E671) 2000 UI; vitamina E (alfa-tocoferol) 25 mg; Vitamina B1 1,5 mg; Vitamina B2 3,5 mg; Vitamina B6 2,4 mg.; Vitamina B12 20 μg; Vitamina K3 1,5 mg; pantotenato de calcio 14 mg; ácido nicotínico 20 mg; ácido fólico 0,5 mg; biotina 50 μg; Fe (E1) (de FeSO4· H2O) 120 mg; I (E2) (de Ca(I2O3)2) 0,75 mg; Cu ( E4) (de CuSO4·5H2O) 6 mg; Mn (E5) (de MnO) 60 mg; Zn (E6) (de ZnO) 110 mg; Se (E8) (de Na2SeO3) 0,37 mg, 560 TXU endo-1,4-ß-xilanasa y 250 TGU endo-1,4-ßglucanasa (EU No. 4a7).
Tabla 2a. Grupo A, B, C en las 2 fases de cría de lechones: componentes del alimento (%).
Tabla 2b. Grupo A, B, C en las 2 fases de cría de lechones: Nutrientes (%).
**Proporciona por kg de alimento: Vitamina A (E672) 5500 UI; Vitamina D3 (E671) 1100 UI; vitamina E (alfa-tocoferol) 25 mg; Vitamina B1 0,5 mg; Vitamina B2 1,4 mg; Vitamina B6 1 mg; vitamina B12 8 μg; Vitamina K3 0,5 mg; pantotenato de calcio 5,6 mg; ácido nicotínico 8 mg; cloruro de colina 120 mg.; Fe (E1) (de FeSO4·7H2O) 80 mg; I (E2) (de Ca(I2O3)2) 0,5 mg; Co (E3) (desde 2CoCO3·3Co(OH)2· H2O) 0,4 mg; Cu ( E4) (de CuSO4·5H2O) 5 mg; Cu (E4) (de quelatos de aminoácidos) 5 mg; Mn (E5) (a partir de MnO) 40 mg; Zn (E6) (de ZnO) 100 mg; Se (E8) (de Na2SeO3) 0,25 mg.
Tabla 2c. Grupo A, B, C en las 3 fases de engorde: componentes del alimento (%).
Tabla 2d. Grupo A, B, C en las 3 fases de engorde: Nutrientes (%).
La comparación de los parámetros medidos entre los grupos experimentales se llevó a cabo mediante ANOVA utilizando el método GLM del programa estadístico SAS. Se eligió un diseño de bloques al azar, siendo el peso inicial y la localización del corral los criterios determinantes para el bloque.
Para el análisis estadístico se tuvo en cuenta el efecto del bloqueo, el sexo y el tratamiento.
El corral fue considerado como la unidad experimental.
Los datos de las tablas se presentan como medias de mínimos cuadrados.
Para los parámetros con un efecto tratamiento significativo, se realizaron comparaciones múltiples entre medias de acuerdo al método de Tukey.

El análisis de los niveles de energía y nutrientes, así como la actividad de la fitasa estuvo dentro del rango esperado. Con respecto a los parámetros de rendimiento, los resultados no mostraron diferencias (p > 0,05) entre los grupos experimentales (B, C) y el grupo control A (Tabla 3a/b) ni en la fase de transición de lechones ni en el global del engorde. Tampoco se observaron diferencias respecto al grupo control (A) para los parámetros óseos medidos (Tabla 3c).
No obstante, se encontró una diferencia significativa en el índice de conversión del alimento entre los grupos experimentales B y C, por lo que el grupo sin contenido de nutrientes disminuido (B) tuvo un mejor índice de conversión.
Estos resultados concuerdan con los reportados por Dusel et al. (2022), quienes tampoco pudieron documentar ninguna influencia negativa en los parámetros de rendimiento y de salud animal en un experimento diseñado desde el destete hasta el final del engorde con la máxima reducción de P y el uso de 6-fitasa híbrida.
La reducción adicional de nutrientes sin pérdida de rendimiento, más allá de la reducción de Ca y P, confirma el aumento de las liberaciones inducidas por la 6-fitasa híbrida de nutrientes unidos a la fitina que se encuentran en los estudios de digestibilidad en cerdos en crecimiento (Trautwein et al., 2017, Winkler et al., 2019; Klein et al. 2022).

Tabla 3a. Efectos de los grupos experimentales sobre el crecimiento y la conversión alimenticia en la fase de transición del lechón (0-41 días de ensayo).
Tabla 3b. Efectos de los grupos experimentales sobre el crecimiento y la conversión alimenticia en la fase de engorde (41-138 días de ensayo); diferentes superíndices indican una diferencia significativa, p<0,05.
Tabla 3c. Efectos de los grupos experimentales sobre el crecimiento y la conversión alimenticia durante todo el experimento (0-138 días de ensayo), así como sobre el peso, la materia seca y el contenido de cenizas del tercer hueso metacarpiano izquierdo (día 138).
Los resultados dejan claro que, si la fitasa microbiana se utiliza en dosis suficientes y si el contenido de fósforo-fitato en el alimento es apropiado, se puede prescindir completamente del P mineral a partir del destete de los lechones.
Con la renuncia a las fuentes minerales de fósforo y el mejor uso del fósforo de origen vegetal inducido por la fitasa, la sostenibilidad económica y ecológica de la producción de proteína animal puede mejorarse mediante la reducción asociada de los costes de alimentación y la reducción de la excreción de fósforo.

Enzimas para aprovechar al máximo el potencial del pienso
• Aumento de digestibilidad de los nutrientes y la energía
• Excepcional estabilidad de proceso y almacenamiento


• Aplicación amplia y flexible
• Mayor eficacia de los recursos

The science of sustainable feed that succeeds

Más que 30 AÑOS
Experiencia pionera Enzimas de BASF


Las micotoxinas son metabolitos secundarios tóxicos producidos por determinados hongos, como Aspergillus, Fusarium y Claviceps spp.
Se trata de sustancias policetónicas que se producen cuando se interrumpe la reducción de los grupos cetónicos en la biosíntesis de los ácidos grasos por parte de los hongos al utilizarlos como fuente de energía.
Las afecciones resultantes de la ingestión de estos metabolitos son las denominadas micotoxicosis y los daños derivados de ellas dependen, en gran parte, de:
Las cantidades ingeridas
La toxicidad de cada molécula
PHD Universidad de MurciaLos hongos requieren un sustrato (generalmente los cereales) para crecer, multiplicarse y producir toxinas y ciertas condiciones de temperatura y humedad:
Humedad del grano > 13%

Temperatura > 20 °C
Humedad relativa del aire > 70%

pH 6-7
Concentración de oxígeno > 20%
Los hongos pueden crecer en el campo, en los silos de almacenaje e incluso en los propios circuitos de alimentación de las granjas cuando las condiciones de humedad o estancamiento lo facilitan.
La presencia de micotoxinas en el alimento puede dar lugar a signos de carácter agudo como:
Anemias
También pueden conducir a signos más leves (subagudos o crónicos) que pueden pasar más desapercibidos como:
Menor velocidad de crecimiento
Peor índice de conversión
Menor consumo de alimento
Disminución de la eficiencia reproductiva
Como consecuencia, las micotoxicosis originan importantes pérdidas económicas en el sector porcino.
Los efectos de las micotoxinas dependen de:
Tipo de micotoxina
Tiempo de exposición
Dosis

La presencia de hongos productores de toxinas en alimentos o materias primas no implica automáticamente toxicidad.
Las materias primas pueden estar infectadas por más de un hongo y cada uno puede producir varias micotoxinas.
Esta combinación puede causar efectos más adversos que una sola micotoxina debido al valor aditivo o interacción sinérgica de las micotoxinas.
Micotoxina

Hasta el momento se han identificado más de 300 micotoxinas.
Sin embargo, las micotoxinas que cobran una mayor relevancia en la alimentación porcina y que guardan relación con la reproducción son (Tabla 1):
Zearalenona (ZEA)
Ergotamina
Tricotecenos (deoxinivalenol -DONy toxinaT-2)
Aflatoxinas
Categoría animal afectada Signos clínicos Lesiones Diagnóstico y tests
Aflatoxinas Lechones
Disminución del crecimiento Alteración del sistema inmunitario
Rechazo del alimento
Diarrea
Toxina T-2
Cerdas
Cerdos de cebo
Deoxinivalenol (DON) Cerdas
Ergotamina Cerdas
Lechones lactantes
Zearalenona (ZEA)
Nulíparas
Multíparas
Verracos jóvenes
Leucopenia
Úlceras orales
Inmunosupresión
Rechazo del alimento Reducción del crecimiento
Agalaxia
Debilidad de lechones
Mortalidad neonatal
Hiperestrogenismo en nulíparas
Pseudogestación
Anestros
Mortalidad embrionaria
Reducción de la libido
Necrosis hepática Hiperplasia del conducto biliar
Úlceras gástricas y orales
Disminución del timo y tejido linfoide
Aflatoxinas en el pienso y metabolitos (B1 y M1) en leche y tejidos
Lesiones histológicas de ulceración
Linfopenia y leucopenia
Análisis del pienso
Terapia/ prevención Residuos
Vitamina E y selenio Aluminosilicatos
Presencia en hígado y leche (no más de 3 semanas)
Cambio de pienso
Tratamiento para la diarrea y úlceras
Poco probable
Pérdida de peso DON ≥ 1 ppm Cambio de pienso No
Inanición en lechones
Necrosis en cola, orejas y pezuñas
Vulvovaginitis
Hipertrofia del útero
Aumento de la progesterona sérica
Ergoalcaloides en pienso u orina
Lesiones perivasculares
Queratinización de la vagina
Aumento de la progesterona sérica
Zearalenol (ZON) en pienso
Evitar el cornezuelo del centeno
Cambio de pienso
Tratamiento para el prolapso
Administrar 100 mg de PGF2α a las cerdas con pseudogestación
(Fuente: Osweiler, 2006).
Pequeñas cantidades (poco significativas)
Se eliminan rápidamente por la orina
Baja probabilidad de residuos
Tabla 1. Características de las principales micotoxinas que afectan a la reproducción porcinaLa zearalenona (ZEA) es una micotoxina producida por Fusarium spp., principalmente F. graminearum, F. culmorum y F. poae. Contamina fundamentalmente los cereales y sus subproductos.

Cuando el nivel de contaminación en el alimento es elevado presenta un aspecto y sabor desagradable que hace reducir bruscamente su consumo, hasta tal punto que el rechazo sirve como factor de alerta.
En cambio, si la presencia de ZEA en el alimento es baja puede afectar a los parámetros reproductivos, provocando importantes pérdidas económicas al incidir negativamente en el calendario de cubriciones, partos y destetes, lo que disminuye sigilosamente la productividad de la granja.
El consumo de ZEA tiene un efecto hiperestrogénico en el tracto reproductivo de las cerdas (vulvovaginitis e hipertrofia del útero) (Imagen 1).
La vulvovaginitis, que incluye tumefacción de la vulva, va acompañada de:
Mastitis con alargamiento de los pezones
Crecimiento desmesurado del útero con ingurgitación de la mucosa genital
Cérvix abierto
Metrorragias copiosas

Los cerdos son muy sensibles a los efectos de la ZEA (Andretta et al., 2008) máximos recomendados en alimentos de 0,1 ppm.
Zearalenona


Otros síntomas son:
Anestro
Infertilidad
Abortos
Prolapsos vaginal y rectal
Aumento de las reabsorciones embrionarias y muerte fetal
Fracaso en los programas de inducción de partos con PGF2α
Mayor incidencia de mortinatos y de lechones con síndrome splay-leg (Imagen 2).

Imagen 2. La intoxicación por zearalenona aumenta la incidencia de lechones con síndrome splay-leg.
Las cerdas jóvenes son más sensibles que las cerdas maduras (Döll, 2004).
En nulíparas el consumo de alimentos contaminados con ZEA en dosis relativamente bajas (1,5 a 2 ppm) provoca inflamación de la pared vaginal y vulvar, aumento del útero, atrofia de los ovarios, etc. (Obremski et al., 2003; Kauffold et al., 2005).
Los signos clínicos aparecen a los 3-7 días tras la administración de la micotoxina y desaparecen a los 14 días tras la retirada de la fuente contaminada (Kordic et al., 1992).

Por otra parte, la ZEA puede inducir la aparición de pubertad precoz en torno a los 70 días de edad (Rainy et al., 1990).
En el caso de las cerdas multíparas, la contaminación por ZEA a niveles de 5-10 ppm después del destete provoca un alargamiento del intervalo destete-celo, cuya duración es directamente proporcional a la concentración de ZEA (Meyer et al.,2000).
Son frecuentes anestros de 50 días o más por la permanencia de cuerpos lúteos en los ovarios (Edwards et al., 1987).
Los principales síntomas por intoxicación de ZEA durante la gestación son:
Falsas gestaciones
Aumento de la mortalidad embrionaria (menor tamaño de camada)
Disminución de la prolificidad y del tamaño de los lechones
Las cerdas primíparas que reciben alimento contaminado (>2,8-3,0 ppm ZEA) al principio de la gestación presentan camadas más pequeñas, con aumento de momificaciones.
En el caso de los verracos, los síntomas más claros y evidentes de exposición a ZEA son:
Inflamación del prepucio
Pezones alargados
Prolapso rectal
Atrofia testicular
Disminución de la libido
Pérdida de pelo
Reducción de la producción y calidad del semen
Signos de feminización
Se ha observado un incremento de la mortalidad durante las dos primeras semanas de vida de los lechones procedentes de cerdas que recibieron niveles de 4,8 ppm de ZEA durante la gestación y la lactancia.

Se cree que la ZEA o sus metabolitos (α- y β-zearalenona) afectan a los lechones a través de la leche de (Palyusik et al., 1980).
También se observa la inhibición temporal de la espermatogénesis, aunque se puede revertir después de la retirada del alimento contaminado.

El ergotismo es una micotoxicosis causada por el consumo continuado de alimento contaminado por el hongo Claviceps purpurea (cornezuelo del centeno), presente habitualmente en diversas gramíneas (cebada, avena, trigo, centeno, triticale).
También pueden participar Claviceps paspalli y Claviceps fusiformis. La intoxicación se manifiesta tras la ingestión continuada de alcaloides presentes en el hongo (ergotoxina, ergotamina y ergonovina, principalmente).
Estos alcaloides provocan:
Agalaxia (Imagen 3)
Camadas pequeñas
Partos prematuros
Momificaciones
Lechones débiles y con bajo peso
Bajas tasas de crecimiento
Altos porcentajes de mortalidad neonatal por inanición de leche y calostro
Repetición de celos
Metritis y mastitis (Barnikol et al., 1982)

La simple retirada del alimento contaminado conduce a una rápida reducción de los signos clínicos.
La sintomatología varía en función de la concentración de alcaloides, duración de la intoxicación y tipo de animal. Con niveles ≥0,53%:
La duración de la gestación se acorta
La probabilidad de abortos y nacimiento de lechones débiles aumenta
Se observan marcados signos de agalaxia en cerdas lactantes
Este efecto sobre la producción de leche es causado por la inhibición de prolactina
Durante el postparto es frecuente observar endometritis con flujo vaginal y celos irregulares, generalmente infértiles.

Aparte de los trastornos reproductivos, la intoxicación por ergotamina puede causar vasoconstricción y daño endotelial que conduce a isquemia y gangrena seca, especialmente en la cola, orejas y pezuñas de los lechones (Imagen 4).
Los lechones afectados presentan anorexia, debilitamiento y aumento de la frecuencia cardiaca y respiratoria.
Imagen 3. Agalaxia en cerda lactante con camada reducida por efecto de la ergotamina. Imagen 4. Ergotismo gangrenoso en un lechón.
La toxina T-2 es una de las micotoxinas más tóxicas y se encuentra en el trigo, centeno, maíz y soja. Es producida por Fusarium tricinctum.
La intoxicación se caracteriza por múltiples hemorragias en la serosa del hígado, estómago y esófago.
Esta toxina tiene un marcado efecto inmunosupresor, siendo sus efectos dosis-dependientes (Rafai et al., 1995).
A nivel reproductivo, la administración de alimentos contaminados (1-2 ppm) en cerdas durante el último tercio de gestación provoca un efecto inhibidor sobre los ovarios (Glavits et al., 1983).
Concentraciones más elevadas de toxina T-2 (12 ppm durante 220 días) ocasionan repetición de celos y camadas pequeñas con bajo peso al nacimiento (Weaver et al., 1978a, b), detectándose metabolitos de toxina T-2 en la leche de las cerdas y en el estómago de los lechones.
El deoxinivalenol (DON) o vomitoxina es producida principalmente por Fusarium roseum o Fusarium graminearum (Imagen 5).

Los alimentos contaminados con DON se asocian con anorexia y disminución en la absorción del alimento, además de inducir vómitos cuando se consumen niveles muy elevados (Diekman y Green, 1992).
La literatura científica pone de manifiesto que el ácido fusárico (FA) aumenta el efecto de DON (Smith et al., 1997), y conduce a una intoxicación más grave por esta toxina.
El FA generalmente está presente en los cereales, pero también puede proceder de otra fuente como la soja.
Imagen 5. Maíz contaminado por Fusarium roseum.Por otra parte, la intoxicación con DON provoca alteraciones del sistema inmunitario (celular y humoral) y trastornos metabólicos en hígado y bazo.
Esto tiene repercusiones a nivel reproductivo a través de la disminución en el desarrollo de ovocitos y embriones (Tiemann y Danicke, 2007; Ranzenigo et al., 2008).
Deoxinivalenol

Las aflatoxinas son producidas principalmente por Aspergillus flavus y Aspergillus parasiticus y están presentes en muchas materias primas de uso frecuente (maíz, cacahuetes, algodón) (Thieu y col., 2008).
Se describen cuatro aflatoxinas, de acuerdo con su fluorescencia a cromatografía:
Azul: Aflatoxinas B₁ y B₂ (AFB₁ y AFB₂)
Verde: Aflatoxinas G₁ y G₂ (AFG₁ y AFG₂)
La AFB₁ se considera como la más tóxica.
Un quinto metabolito, aflatoxina M₁ (AFM₁), se detecta en la leche de animales que han ingerido pienso contaminado con AFB₁.
Las aflatoxinas B₁, G₁ y M₁ pueden estar presentes en la leche de la cerda (Silvotti et al., 1997).
Las intoxicaciones experimentales han demostrado daño en linfocitos y macrófagos en los lechones, provocando un debilitamiento del sistema inmunitario.
Por otra parte, las aflatoxinas provocan rechazo del alimento y reducción del crecimiento.
Los signos clínicos de la aflatoxicosis aguda son:
Anorexia Signos nerviosos
Muerte súbita (Hale y Wilson, 1979).

Impacto de las micotoxinas en la reproducción porcina
DESCÁRGALO EN PDF

Lechones de alta calidad: peso y homogeneidad al nacimiento

Descendientes con alto potencial de crecimiento y de IC

GRASA DORSAL < 6.3mm
Unos machos elegidos para sus calidades de canal y su rendimiento para todas las oportunidades
GMD > 1 100
Un excelente crecimiento
Calidad de canal con buena clasificación al matadero
IC < 2.09
Un macho rentable con uno de los costes alimenticios más bajos del mercado

En el pequeño municipio de Sora, en la comarca de Osona (Barcelona), se localiza la Granja Solallong, una granja de Diamante. Allí nos espera Joaquim Rovira, su propietario y ganador del Premio Porc d’Or con Diamante 2023, el máximo galardón de los Premios Porc d’Or.
A nuestra llegada, observamos que la finca se localiza entre el verde de varias montañas y de un paisaje idílico, algo que caracteriza a la Granja Sollalong. Tal como nos comenta su propietario, trabajar en ese entorno es un privilegio diario.

“Durante toda la vida me había gustado mucho el mundo del deporte. De hecho, también había practicado trial, ya que en aquella época era algo muy común en esta zona de Cataluña”.
“La Granja Solallong está en la subcomarca de Bisaura, en Osona. Por suerte para nosotros no es una zona con mucha densidad de explotaciones porcinas. El término Sola procede de solar, de campo, mientras que Llong hace referencia a largo. Solar largo, en cuestión”.

ser hijo de familia ganadera, Joaquim Rovira se distanció del sector al finalizar sus estudios para focalizar su trayectoria profesional en una rama completamente diferente a la ganadería. En invierno, profesor de esquí, en verano, profesor de esquí acuático. Desarrolló esta profesión hasta los 30 años, ya que era, desde


Su etapa como piloto de trial se cerró tras correr los Seis Días de Escocia de Trial, también conocido como Scottish Six Days Trial. Según cataloga Joaquim Rovira, un verdadero amante del deporte, se trataba de la prueba más importante del mundo como amateur destacado.
En 1985 nuestro protagonista dejó de trabajar de profesor de esquí y se decantó por seguir la tradición familiar: la ganadería. Joaquim encontró la inspiración en sus padres y abuelos quienes le animaron a aventurarse en el mundo de la producción porcina.
De hecho, su padre le ayudó a construir la primera nave en la que tenían 100 madres. Desde entonces, lleva 38 años trabajando en la misma granja, la Granja Solallong.

Si algo caracteriza a la Granja Solallong es el trabajo en equipo y el gran capital humano que hay detrás de tantísimos años de trabajo. De hecho, Joaquim Rovira nos confiesa que si no fuese por el excelente equipo humano que tiene, al que ve muy comprometido y feliz, él ya no seguiría trabajando allí. Ahora bien, entre los ocho empleados que trabajan en la finca, Rovira destaca a uno en particular: Toni Portell.
“Toni Portell es el encargado de la granja y lleva trabajando aquí dos años menos que yo, es decir, 36. Empezó a los 14 años, cuando estudiaba prácticas agrarias e hizo sus prácticas aquí. Desde entonces, es una persona fundamental en el día a día de la granja. Él fue el primero en el que pensé cuando me nombraron ganador del premio”.


Desde que empezamos a trabajar con PigVision, hemos ganado dos horas a la semana en mano de obra”. Daniel Biedemann, ganadero en Alemania
Manejo fácil e inteligente para la gestión de granjas de producción porcina
a Información en tiempo real
a Mayor eficiencia
a Fácil de usar
a Aplicación móvil para iOS y Android
a Posibilidad de trabajar sin conexión
a Soporte español gratuito
Encuentra más información aquí
www.agrovision.com/es


Teléfono: +34 960 130 261 - WhatsApp: +34 612 584 141
support-es@agrovision.com

















Más allá de Toni Portell, Joaquim también recuerda con cariño a su padre, ya que fue el impulsor y su ejemplo a seguir desde sus inicios en la ganadería, y para todo su equipo de trabajo, evidentemente.








Tras tres nominaciones seguidas, finalmente el Premio Porc d’Or con Diamante acabó en manos de Joaquim Rovira en la 30ª edición de los Premios Porc d’Or. Según señala nuestro protagonista, es una distinción que pone en valor los muchísimos años de trabajo bien hecho, de continuidad y de ser siempre los mismos.
Pero no solo eso, sino que Rovira también considera que el hecho de haber estado siempre en el mismo sitio, desde que se inició en el sector con 100 madres hasta ahora que tiene más de 1.050 cerdas, es otro de los aspectos clave.

“Nos ha costado muchos años llegar, pero es un auténtico hito para nosotros. La satisfacción es total. No es un trabajo específico, sino el trabajo de muchos años de todo el personal que trabaja en la Granja Solallong. Desde que trabajaba de profesor me ha gustado hacer las cosas bien y el resultado ha sido favorable”.
Más allá de los paisajes y de la naturaleza, si algo nos sorprende al llegar a la granja Solallong son las estrictas medidas de bioseguridad que se aplican para evitar la entrada de patógenos al recinto.
Para acceder, debemos cambiarnos de vestimenta y ducharnos, mismo proceso que repetimos al dejar la explotación. Asimismo, los camiones que transportan animales vivos también se desinfectan en la entrada.


“Las normas que hemos puesto siempre las hemos cumplido a rajatabla. En el tema de bioseguridad hemos vigilado muchísimo. También tenemos especial cuidado con la gente que ingresa en la granja, ya que nunca sabes si van a ser portadores de virus”.


En la Granja Solallong no solo se piensa en el presente, sino que se trabaja con la mirada puesta en el futuro. Uno de los retos que tienen a corto plazo es mantener la granja al día, cumpliendo con las exigencias legislativas y del consumidor. En este sentido, Joaquim Rovira nos comenta que ya trabajan en los cambios que exige la normativa relativa a la presencia de amianto en los techos.
“En el caso del amianto hemos avanzado mucho, ya que la normativa se aplicará a partir del 2030. Sin embargo, consideramos que era un buen momento para hacerlo”.



Antes de abandonar la Granja Solallong, Joaquim Rovira nos regala una reflexión muy personal:
“Para hacer este trabajo tiene que gustarte mucho. Yo me lo he pasado muy bien durante todos estos años y he disfrutado, pero también he sufrido mucho. Tal vez he tenido suerte o he sabido hacerlo, quién sabe, pero es un trabajo que requiere esfuerzo y mucha pasión. No lo puede hacer cualquiera”.

El equipo de porciNews ha tenido el privilegio de poder visitar la Granja Solallong y conocer el lado más personal de Joaquim Rovira, su propietario y ganador del premio Porc d’Or con Diamante 2023. No se trata de una granja cualquiera, sino de una granja de Diamante.
DESCÁRGALO EN PDF
Granja Solallong, una granja de DiamanteServicio Técnico de Boehringer Ingelheim Animal Health

Los días 20 y 21 de septiembre, la Jornada “Objetivo Primerizas” de Boehringer Ingelheim Animal Health España llegó a las ciudades de Madrid y Lleida en dos sesiones consecutivas que contaron con la asistencia de más de un centenar de profesionales de todo el país.
“Con esta iniciativa, hemos querido crear el foro idóneo en el que hablar de unos animales que tienen un valor muy especial en la granja: las cerdas de reposición que se van a convertir en primerizas. Rodeados de los mejores expertos, hemos recorrido el camino para poder conocer muy bien cómo explotar al máximo el potencial de estas cerditas y obtener el mejor rendimiento”, explica Gisela Girmé, Brand Manager de Porcino de Boehringer Ingelheim Animal Health España.

En línea con el compromiso con la formación de Boehringer Ingelheim Animal Health España, la jornada se desarrolló con el objetivo de presentar la visión de la compañía respecto al manejo de las primerizas y su seguimiento en la granja. Además, se abordaron los planes vacunales como uno de los temas estratégicos en cuanto a la salud porcina.
En una constante búsqueda para lograr maximizar la productividad y el rendimiento de las explotaciones, la sesión giró en torno a las cerdas primerizas, ya que “a menudo olvidamos que las primerizas juegan un papel protagonista, pues representan el futuro de la granja”, puntualiza Gisela Girmé.
Poniendo el foco en esta cuestión y tomando como punto de partida que se debe dar la bienvenida al animal de máximo valor en la explotación, se hizo especial hincapié en las necesidades de las granjas de porcino.
El evento comenzó con la intervención de Isaac Huerta (PIC - Pig Improvement Company), quién explicó las “Claves del éxito para un correcto desarrollo de la primeriza”.
Bajo este enfoque, habló del manejo de la reposición desde el punto de vista de una empresa proveedora genética para maximizar el potencial genético y poder garantizar la adaptación adecuada.

Recordó las cuestiones básicas de manejo de las futuras madres, relacionadas con la selección y aptitud de las cerdas de reposición, la pubertad y la elegibilidad, la edad y peso de la primera cubrición, para finalmente remarcar la importancia de la condición corporal y de una correcta estrategia de alimentación hasta la primera gestación.

Posteriormente tomó la palabra Antonio Martínez Gilaberte (Vall Companys) quien, abordando la necesidad de “adaptarse o morir”, compartió con al auditorio su experiencia como veterinario de una empresa integradora. Así, empezó hilando algunos datos expuestos por Isaac Huerta para después entrar en materia y abordar la adaptación desde dos perspectivas: la reproductiva y la sanitaria.
Desde el punto de vista sanitario, hizo un amplio repaso de los fundamentos, los distintos métodos utilizados hoy en día (pasivo, inoculación, semilleros y vacunación) y los objetivos de cada uno de ellos.
En tercer lugar, Luis Sanjoaquín (ThinkingPig) intervino con la ponencia “Primerizas: alargando la vida productiva”.
En el eje de su discurso, un tema: la importancia crucial del manejo de las maternidades hasta el primer parto, ya que impacta de forma directa, tanto en la salud de las cerdas como en la vitalidad de las camadas.

En su exposición, Luis Sanjoaquín estableció los pilares para optimizar al máximo la vida productiva de las cerdas mediante el control de los factores que afectan a las pérdidas (ambientales, estrés, alojamiento y condición corporal).
Luis ofreció un gran abanico de recomendaciones para realizar un correcto manejo durante la primera gestación, hasta el primer parto.

Ya en el último turno de palabra, Rocío García (en la sesión de Madrid) y Glòria Abella (en la sesión de Lleida), del equipo técnico de Boehringer Ingelheim Animal Health España, fueron las encargadas de hablar sobre la salud preventiva, mostrando las claves y pautas de la vacunación de las cerdas primerizas.
No faltó una aproximación a los planes vacunales que garantizan la SALUD y BIENESTAR a lo largo de la vida de la cerda, además de contribuir a la PRODUCTIVIDAD en el ciclo reproductivo del animal.
Con el título “FLEX Reproductive: nuestra aproximación más práctica”, se desarrolló una interesante ponencia que abordó el momento crucial del parto.
Así, se comenzó explicando la relación entre el parto y el dolor, para después revisar su importancia, los indicadores a tener en cuenta y las distintas soluciones presentes en el portfolio FLEX Reproductive de Boehringer Ingelheim con indicación para el momento del parto.
Finalmente, la jornada concluyó con una mesa redonda muy participativa en base a las preguntas que los asistentes fueron dejando durante la jornada.
Moderada por Vicente Blasco (Jisap), en Madrid, y por Nacho Tardío (Cincaporc), en Lleida, la mesa contó con la presencia de todos los expertos con el objetivo de dar respuesta a cuestiones específicas o ahondar en los aspectos que más interés despertaron entre los allí presentes.
Con un gran éxito de convocatoria, la Jornada “Objetivo Primerizas” generó el ambiente propicio, no solo para poder aprender de los mejores expertos en la materia, sino para poder interactuar entre los profesionales que se dieron cita en ambas ciudades. Esta iniciativa:
Logró dar visibilidad a la importancia de las cerdas primerizas como los animales de más alto valor de la explotación.
Analizó por qué es vital que las cerdas de reposición reciban la mejor bienvenida a la granja y por qué debemos esforzarnos en adaptarlas de forma adecuada.
En esta línea, la intervención de los distintos ponentes demostró que las cerdas primerizas bien adaptadas tienen un mejor desempeño en su primer parto. Un hecho que no solo tiene su impacto en la salud y el bienestar de la cerda, sino que se refleja también en camadas más saludables.
Durante toda la jornada se trató de remarcar la necesidad de colocar y consolidar unos sólidos cimientos para favorecer el éxito de la granja, tanto a medio como a largo plazo. Asimismo, se remarcó que, si la cerda comienza su carrera reproductiva de una manera exitosa, es más sencillo que se pueda mantener ese nivel de rendimiento en crías futuras y esto se traduzca en una mayor longevidad y productividad a lo largo de toda su vida.
MÁS INFORMACIÓN: WWW.SOLOPORCINO.ES/REPRODUCTIVO
Objetivo primerizas: Boehringer Ingelheim pone en valor la figura de las cerdas primerizas para optimizar productividad y rendimiento DESCÁRGALO EN PDF
proteger su explotación porcina incluso en las condciones más difíciles.
Las soluciones de filtración de aire de AAF protegen a Cincaporc contra los brotes de PRRS.


Nuestras avanzadas soluciones de filtración de aire detectan y eliminan partículas nocivas, patógenos y olores, garantizando una calidad de aire óptima en sus granjas. Proteja a sus animales de los problemas respiratorios causados por contaminantes presentes.

en el aire y mejore su bienestar general. Si le preocupa la calidad del aire de sus instalaciones, puede contactar con nosotros:
Customer.ServiceSP@aafeurope.com
+34 916 62 48 66 • phone: +34 916 62 48 66


Prefiltro: RedPleat de eficacia ISO Coarse 70%, con marco de plástico totalmente incinerable y una baja pérdida de carga inicial para un bajo consumo de energía. Filtro principal: BioCel V XL A 95% de eficiencia @MPPS, media resistente a la humedad, construcción sellada al 100% para evitar cualquier fuga, construcción de plástico totalmente incinerable con rejillas de protección, gran superficie filtrante con muy baja pérdida de carga inicial para un bajo consumo de energía. Marcos portafiltros: FA Seal con una construcción soldada para una instalación sin fugas de los elementos filtrantes, con clips de acero inoxidable para una correcta compresión que garantizan una instalación y un mantenimiento rápidos y seguros, sin necesidad de muelles o elementos aparte. Para más información, visite aafeurope.es

Escanee el código QR para ver cómo las soluciones de filtración de aire de AAF protegen las explotaciones porcinas de Cincaporc contra los brotes de PRRS.
Interprofesional agroalimentaria del porcino de capa blanca (INTERPORC)
Inés Ruedas-Torres1, Jaime Gómez-Laguna1, Guillermo Ramis2, Cinta Prieto3, Enric Mateu4, Gerard Martín-Valls4, Ivan Díaz5, Carles Vilalta5, Francisco Javier Martínez-Lobo6, Lorenzo Fraile6 y Jordi Baliellas7,8
1Universidad de Córdoba, 2Universidad de Murcia, 3Universidad Complutense de Madrid, 4Universitat Autònoma de Barcelona, 5CRESA-IRTA, 6Universitat de Lleida, 7Grup de Sanejament porcí de Lleida, 8INTERPORC
El PRRS ocasiona un impacto económico importante en sus distintas presentaciones clínicas. Además, facilita la presencia de complicaciones bacterianas, lo que repercute directamente en el uso de antimicrobianos.
Los pilares básicos en la prevención y el control del PRRS son:

A nivel general, se recomienda una clasificación de las granjas según su estatus de PRRS, valorando el riesgo ponderado de cada explotación y estableciendo una red de contactos y movimientos con el objeto de minimizar la diseminación del virus en una región.
A continuación, repasamos los 10 puntos clave para hacer frente al PRRS en las explotaciones porcinas.
La cuarentena debe ser en unidad independiente y con monitorización serológica a entrada y salida.
Los centros de inseminación artificial (CIAs) deben situarse en zonas de muy baja densidad porcina y aplicar estrictas medidas de bioseguridad. 1 2
Los programas de monitorización en los CIAs deben contemplar análisis frecuentes y rutinarios mediante diagnóstico por PCR y ELISA, preferentemente en suero.
En el caso de la compra de animales, se deben exigir unas garantías sanitarias: Nulíparas y verracos: ausencia de infección en base a doble análisis (PCR y ELISA).
Lechones: que provengan de orígenes con flujo negativo.
Programar la entrada de partidas de lechones positivos únicamente en zonas de baja densidad de granjas de reproductoras.

3
4 5
Fomentar la comunicación entre veterinarios, ganaderos y otros actores que intervienen en la gestión sanitaria del país para alertar de brotes y de la presencia de cepas de alta virulencia en una zona.
Artículo adaptado del “Decálogo de buenas prácticas en la Prevención y Control de la enfermedad del virus PRRS en las granjas porcinas españolas” de INTERPORC
Seguir las recomendaciones de la EMA para evitar recombinaciones entre distintas cepas de virus PRRS.
Vacunar a los lechones solo cuando el porcentaje de virémicos en la población sea nulo o bajo.
La logística de movimientos de personas, vehículos y animales debe establecerse por criterios sanitarios.
Formación continuada en bioseguridad del personal interno y externo para una gestión biosegura en aspectos clave como:
Gestión de los cadáveres (cambio de ropa, calzado, uso de guantes).
Muelles de carga y descarga de los animales.
Aplicar los máximos estándares de bioseguridad interna en producción porcina:
Manejo por lotes y sistemas de trabajo todo dentro /todo fuera con vacío sanitario.

Control de los movimientos internos del personal.


Servicios Genéticos PIC®

Parámetros productivos asociados a prolificidad y eficiencia de crecimiento entre otros, están mejorando año a año en

La impresionante aceleración del potencial genético que estamos observando en estos momentos se asocia a la implementación de avanzadas tecnologías aplicadas a la recogida y análisis de datos fenotípicos y genómicos.


Actualmente, el ritmo de mejora es tan rápido que un programa genético centrado en mejorar prolificidad generaría valores comerciales cercanos a 45 destetados/cerda/ año en solo 10 años.
Tal predicción en mejora de prolificidad era considerada como altamente positiva por muchos productores, sin embargo, el enfoque en incrementar el número de lechones no parece ser hoy tan importante como hace unos años.
La creciente concienciación social en materia de bienestar animal y sostenibilidad ambiental, con el consecuente reflejo en normativas europeas, están cambiando las prioridades del productor porcino.
Por ello estamos convencidos de que el éxito de los programas de mejora genética del futuro no vendrá tan determinado por el número de lechones sino por los kilos de carne vendidos por cerda y año, siendo ésta una carne de calidad, con alto retorno económico para el productor, producidas de forma sostenible y respetuosas con el bienestar animal.
El reto para las empresas de mejora genética es enorme, requerirá irremediablemente de un nuevo enfoque en el que caracteres asociados a la rusticidad de los animales comerciales y a la longevidad de los reproductores serán altamente prioritarios dentro del programa genético.
Si bien, nadie duda de la mejora constante de parámetros relacionados con prolificidad, eficiencia de crecimiento y caracteres de canal, sí parece existir una creciente percepción de pérdida de rusticidad en las granjas de producción, especialmente en las cerdas reproductoras.
La preocupación en la industria está justificada ya que una menor longevidad y rusticidad de la cerda se asocia directamente a:
Peor rentabilidad del sistema de producción.

Impacto negativo sobre el bienestar animal.
Peor sostenibilidad.
Para PIC® es fundamental actuar ante los desafíos presentes y futuros del productor porcino.
En una industria en constante cambio (restricción en el uso de antibióticos, prohibición del óxido de zinc en las dietas, las normas de bienestar, desafíos sanitarios, etc.), consideramos de máxima importancia producir reproductores más robustos y longevos que generen un producto comercial capaz de hacer frente a todos estos desafíos, mejorando además los niveles de productividad y eficiencia en la granja.
Las nuevas tecnologías de análisis de imágenes digitales, inteligencia artificial e inversión en selección genómica han hecho posible actualizar el Programa Genético de PIC® mediante la inclusión de nuevos caracteres con un impacto directo en la longevidad y rusticidad de nuestros animales.

El novedoso enfoque de PIC® para mejorar la rusticidad y longevidad impacta a todas las líneas maternas y terminales, mejorando de este modo:
Hembras reproductoras.
Cerdo comercial de engorde.

Programa GNX de Líneas Terminales
Para lograr este impacto en todos los animales de la pirámide de producción, lo primero ha sido expandir el Programa GNX de Líneas Terminales (Figura 1), activo desde el año 2007.
Este programa genera datos a partir de información recogida a nivel individual en cientos de miles de animales (150.000 solo en 2022) sobre:
Mortalidad en cebo.
Defectos congénitos.
Canal y calidad de carne.
Programa GNX de Líneas Maternas
Paralelamente, PIC® ha desarrollado un nuevo Programa GNX de Líneas Maternas (Figura 1) con un enfoque directo en:
Aumentar la longevidad de la cerda.
Reducir la mortalidad de reproductoras.
Minimizar los días no productivos.
+150.000 animales/año
Selección
Línea Hembra: Éxito 1ª, 2ª, 3ª monta, tasa de retención a parto, causas de baja de hembra.
Datos comerciales
Línea Finalizador: Mortalidad desde nacimiento, defectos congénitos, datos planta procesado.
El programa GNX Materno comenzó a funcionar en el 2020. Desde entonces, ha generado un flujo creciente de datos fenotípicos y genómicos recogidos en decenas de miles de cerdas puras y cerdas comerciales F1 producidas en condiciones comerciales.
Ambiente Granja élite Granja Comercial Cerdos a matadero Datos Línea pura Figura 1. Esquema de los Programas GNX en Líneas Terminales y Maternas de PIC®.Se recogen todos los caracteres asociados a la rusticidad y longevidad de la cerda reproductora como:
Éxito a la primera, segunda y tercera cubrición.
La tasa de retención a parto 1, 2 y 3.
Detalle exhaustivo de las razones de baja de la cerda.
Razones precisas de mortalidades.
Defectos congénitos.
Una vez que toda la información es recopilada a nivel individual y combinada con los datos genómicos y de pedigrí, estamos entonces en disposición de estimar los valores reproductivos (EBVs) de los nuevos caracteres de rusticidad.
El primer carácter resultado del programa GNX Materno que entró en el programa genético de las líneas maternas lo hizo en julio del 2022 (Figura 2)
Este carácter se centra en la mejora genética de las principales causas de mortalidad y baja prematura de las cerdas.

Recientemente, en julio del 2023 se incluyeron en el programa genético dos caracteres más (Figura 2):
Probabilidad de la cerda reproductora de llegar con éxito al segundo parto.
Fenotipado digital de aplomos y estructura como resultado de una fuerte inversión en tecnología de fenotipado de precisión.
2022 2023
Adición en el índice de rusticidad y longevidad mediante los datos generados en el programa GNX materno
Nuevo caracter - Éxito reproductivo
Nuevo caracter - Fenotipado digital de aplomos y estructura
Figura 2. Nuevos caracteres incluidos en el programa genético derivados del programa GNX Materno.
Esto es solo el principio. Con el tiempo, los programas GNX Materno y Terminal seguirán expandiéndose, generando más volumen de datos y más genotipos con lo que podremos refinar las valoraciones genéticas y añadir nuevos caracteres al programa genético de rusticidad y longevidad.
La inversión en genotipado de reproductores que PIC® comenzó en el 2013, ha crecido año a año. El número de animales genotipados solo en el año 2022 fue de más de 250.000.
El uso de la genómica a gran escala está claramente justificado por el incremento significativo en la precisión de las estimaciones genéticas.
La mayor precisión es particularmente importante en la mejora de esos caracteres que no pueden medirse en el candidato a la selección, como es el caso de la mayoría de los caracteres relacionados con rusticidad.

podemos estimar con precisión cómo va a comportarse su descendencia con respecto a la mortalidad en cebo.
Los avances tecnológicos nos permiten refinar cada vez más las evaluaciones genéticas y seleccionar por caracteres que antes no podíamos ni imaginar.
Las nuevas tecnologías de análisis de imagen y video mediante inteligencia artificial han abierto un nuevo mundo de oportunidades en la mejora genética porcina: el fenotipado de precisión.
Desde julio de 2023 PIC® incluye en programa de mejora genética el fenotipado digital de patas y estructura de los reproductores.
Este enfoque, único en la industria porcina, implica la transición de valorar aplomos mediante el “ojo” de un experto en selección, a que sea la inteligencia artificial (IA) la que haga las valoraciones, con el consiguiente incremento de objetividad de los datos recogidos. Esto es posible gracias a que los algoritmos de la IA pueden analizar imágenes digitales generando, para cada animal, unos 200 valores de longitudes y angulaciones de su estructura corporal.
¿Cómo puede la IA artificial predecir la longevidad del animal?

Como proveedor de genética, en PIC® trabajamos para apoyar el éxito futuro del productor mejorando aquellos caracteres clave para la industria. Para ello, debemos ser sensibles a los retos actuales de los productores e incluso predecir los retos futuros.
Entre estos, la mejora de la longevidad de los reproductores y la rusticidad de los cerdos comerciales supone a día de hoy uno de los principales desafíos para el productor porcino y, por ende, para una empresa de mejora genética como PIC®.
Si bien somos conscientes de que el componente genético de estos caracteres tiende a ser limitado, la fuerte inversión tecnológica a nivel genómico y de recogida de fenotipos de forma precisa y a gran escala nos ha permitido incluir en el programa genético nuevos caracteres con un impacto directo en la mejora de la rusticidad y longevidad de nuestras líneas para así ayudar a maximizar el éxito de los productores.
Últimos avances en la mejora genética porcina: Mejora de la rusticidad y longevidad en líneas PIC® DESCÁRGALO EN PDF
1 2 3
Desde el 2020, decenas de miles de reproductores han sido evaluados por esta tecnología de IA (Figura 3) generando datos de aplomos y estructura.
Posteriormente, dicha información se ha asociado a los datos de rusticidad-longevidad que esos mismos animales han generado en toda su vida productiva.
Combinando toda esta información con los datos genómicos y de pedigrí, estamos en disposición de predecir cuál es la probabilidad de supervivencia de los reproductores (longevidad) y añadirlo al programa de mejora genética en todas nuestras líneas en forma del nuevo carácter Fenotipado Digital de Aplomos y Estructura.
Figura 3. Ejemplo del análisis digital de imagen realizado por el algoritmo de la IA.El progreso genético óptimo entregado con la máxima calidad y sanidad
Magro Homogeneidad
Verracos terminales líderes que proporcionan canales apreciadas en la industria
Dosis seminales producidas en centros exclusivos protegidos por el programa sanitario de referencia
CASA
La tecnología más avanzada y una completa trazabilidad para apuntalar su éxito productivo
El progreso genético que necesita para asegurar su competitividad, gestionado de forma óptima

Dosificador
Dos7
Silos de almacenaje


Circuito de cadena


Discaflex
Máquina de gestación
electrónica Intellitek

DISTRIBUIDORES OFICIALES DE:
Central
Camí de Flix, s/n
25186 Llardecans (Lleida)
Delegaciones
San Clemente (Cuenca)
Sevilla





Salida
Ventilador


Sistema


Tolva

Red
T:

LA
Desirée Martín Jurado y Mireya Melero Pérez
Exopol S.L.

En la producción porcina, la fase de lactación suele durar 3-4 semanas. Se trata de un momento delicado, ya que el lechón es muy inmaduro y cualquier patología puede desencadenar un grave problema en esta etapa o incluso repercutir en las siguientes fases de producción.
Para implementar las medidas preventivas adecuadas y a tiempo, es muy importante llevar a cabo un diagnóstico preciso de las diferentes patologías que afectan a los lechones a esta edad.
En este artículo abordaremos el diagnóstico laboratorial que se puede realizar en la fase de lactación en función del proceso patológico, pero antes de ello, se debe tener claro qué animales seleccionar para la toma de muestras.
se seleccionan?

Los antibióticos pueden inhibir el aislamiento bacteriano, llegando a resultados inconclusos.
Animales con sintomatología clínica
Animales no tratados
Animales sacrificados
Se recomienda seleccionar animales que estén al inicio del proceso para detectar los agentes primarios.
También se pueden enviar muestras de animales con más tiempo de evolución para identificar los agentes secundarios que, en ocasiones, son los desencadenantes de las bajas.

Enviar muestras de más de un animal

Es importante analizar varios animales para asegurar que los resultados obtenidos son representativos a nivel de grupo.
Imagen 1. Necropsia de dos lechones en fase de lactación con patología digestiva.
En los procesos digestivos se ha de tener en cuenta el equilibrio del microbioma intestinal, ya que existen bacterias como Clostridium perfringens, Escherichia coli, Clostridioides difficile o Enterococcus sp. que forman parte de la microbiota normal pero que pueden dar lugar a procesos diarreicos si ese equilibrio se rompe a causa de disbiosis o de la presencia de cepas con factores de virulencia.

ventajas de cara a realizar un monitorizaciones de portadores de patógenos digestivos más habitualmente en animales de transición o cebo.
Es importante remarcar que son una muestra adecuada para diagnóstico.

Calzas
 Imagen 2. Paquete digestivo porcino con enteritis catarral.
Tabla 1. Técnicas laboratoriales disponibles para cada tipo de muestras para el diagnóstico de procesos digestivos.
Imagen 2. Paquete digestivo porcino con enteritis catarral.
Tabla 1. Técnicas laboratoriales disponibles para cada tipo de muestras para el diagnóstico de procesos digestivos.



Se realiza a partir de muestras de los paquetes intestinales para establecer relación entre el agente infeccioso implicado y la sintomatología que
La qPCR (PCR a tiempo real) es apta para todos los patógenos implicados y aporta la posibilidad de confirmar la presencia de patógenos no cultivables o de cultivo difícil, así como patógenos que están en concentraciones muy bajas.
Técnicas Muestra E. coli C. perfringens C. difficile Isospora suis Enterococcus hirae
Cultivo y aislamiento bacteriano
PCR
Paquetes digestivos, hisopos rectales y heces X X X X
Paquetes digestivos, hisopos rectales, heces y calzas X X X X X
Rotavirus PEDV
Tabla 2. Técnicas para la detección de agentes implicados en procesos digestivos en lechones lactantes.E. coli es un agente etiológico de gran relevancia en la diarrea de lechones lactantes, existiendo diversos patotipos en función de las fimbrias, adhesinas y toxinas que producen.
Las diarreas en lactación se asocian a E. coli enterotoxigénico (ETEC) cuyos principales factores de virulencia son:

Las fimbrias o adhesinas F4 (K88) F5, F6, F18 y F41.
Diversas enterotoxinas que pueden ser termolábiles (LT) y termoestables (STa, STb, EAST1).
Estos factores de virulencia implican que exista una gran variedad de patovirotipos.


C. perfringens y C. difficile son agentes causantes de enteritis a partir de la primera semana de vida de los animales.
C. perfringens tipo A y C pueden provocar diarreas neonatales, aunque el tipo C es más invasivo y tiene una morbilidad elevada y una mayor mortalidad. Todo ello depende de los toxinotipos presentes, así como de la patogenicidad que está relacionada con la presencia de diversas toxinas.
En todos estará presente la toxina alfa, pero la que cobra mayor relevancia por su poder patógeno es la toxina beta o CPB2.
Esta determinación se puede hacer mediante PCR, estudiando su presencia y sus toxinas.
Rotavirus y PEDV son los principales virus implicados en las diarreas en lechones lactantes, produciéndose la transmisión por vía orofecal.

Rotavirus tipo C es más prevalente durante la primera semana de vida, mientras que Rotavirus tipo A suele presentarse en animales de 3-5 semanas de vida.
PEDV puede producir cuadros epidémicos, ocasionando una alta mortalidad en lactación.
Imagen 3. Enteritis catarral porcina compatible con E. coli.Las muestras recomendadas para el diagnóstico de procesos pulmonares son:
Pulmones
Se trata de la muestra con la que se pueden llevar a cabo más técnicas diagnósticas, pero tienen el inconveniente de que requiere que los animales hayan causado baja o hayan sido sacrificados.
En el caso de agentes primarios, no ser representativo si no procede de un animal al inicio del proceso.

Hisopos
Son muestras tomadas por personal formado y tienen la ventaja de ser representativas de los patógenos presente en vías bajas y se pueden dirigir a animales sintomáticos al inicio del proceso ya que se realiza la toma de muestras en vivo.
Raspados traqueobronquiales
Se pueden tomar muestras de diferentes zonas (nasales, laríngeos,
Imagen 4. Pulmón de lechón con neumonía fibrinosa multifocal con cierto grado de consolidación.
Muestras


Imagen 5. Toma de muestra respiratoria mediante raspado traqueobronquial.
Tabla 3. Tipos de muestra para diagnóstico respiratorio.Los procesos respiratorios suelen ser mixtos con implicación de diferentes agentes infecciosos (Tabla 4). En el complejo respiratorio es importante diferenciar entre agentes primarios (producen enfermedad en ausencia de otros patógenos) y agentes secundarios u oportunistas.
La mejor muestra para llevar a cabo el diagnóstico de procesos asociados a Influenza A son los hisopos nasales a partir de los que se puede realizar qPCR, tipado y secuenciación para conocer qué subtipo está presente en las granjas.

En la actualidad, la presencia del PCV-2 en las granjas está controlada a través de la vacunación.
Cursa con rinitis, neumonía y abortos y repeticiones por la fiebre que produce.
Para abordar el diagnóstico del PRRS se debe tener claro si se quiere realizar:
El diagnóstico de un proceso clínico (animales con sintomatología).
La monitorización y control de la enfermedad.
La serología es una buena técnica para conocer el estatus de la granja y el nivel de anticuerpos de los animales.
Respecto al PCV-3, todavía está en estudio su grado de implicación y patogenicidad en estos procesos.
Existen otros agentes bacterianos como A. pleuropneumoniae, agente primario en procesos respiratorios, en los que se puede realizar el serotipado mediante qPCR, pero, en caso de animales en esta fase de producción, no es tan relevante.

Las pruebas diagnósticas se pueden dirigir a:
La detección del virus mediante qPCR.
La detección de anticuerpos a través de serología.
Realizar la comparación filogenética entre diferentes cepas víricas con la secuenciación.

Técnicas Muestra Influenza A PRRS PCV2 - 3
Cultivo y aislamiento bacteriano
PCR
Tipificación
Pulmones, hisopos y raspados traqueobronquiales
Bordetella bronchiseptica
Pasteurella multocida toxinogénica
Mycoplasma hyopneumoniae
Mycoplasma hyorhinis
Glaesserella parasuis
Streptococcus suis
Secuenciación X X X X
Pulmones, sangre/suero, hisopos, raspados traqueobronquiales y fluidos orales
Serología Sangre/suero X X X X
Para el diagnóstico de procesos nerviosos y articulares las muestras de elección son encéfalos y articulaciones, respectivamente.
Un método sencillo de muestreo de encéfalo es la introducción de un hisopo estéril por el agujero magno.
En problemas articulares se pueden tomar muestras de líquido articular, lo que presenta la ventaja de poder realizarse en animales in vivo al inicio del proceso, evitando el sacrificio.

Tabla 5. Muestras para diagnóstico de procesos articulares en lechones lactantes.
Muestras Muestra animal vivo Representativa del colectivo Aislamiento de cepas
Hisopo articular X
Líquido articular X X X
Imagen 6. Toma de muestra de encéfalo mediante hisopado a través del agujero magno.

Imagen 7. Articulación afectada de lechón en fase de lactación.
Tabla 4. Muestras, técnicas y principales agentes implicados en procesos respiratorios en lechones lactantes.Muestras Histopatología Muestra animal vivo Representativa del colectivo Aislamiento de cepas
Hisopo agujero magno X
Líquido pericárdico X
Sangre X X
Órganos poliserositis X X
Las artritis infecciosas se manifiestan como poliartritis, siendo Streptococcus suis, Glaesserella parasuis y Mycoplasma hyorhinis agentes que pueden ocasionar problemas articulares en los lechones tras infectarse a partir de la madre por vía respiratoria o, incluso, en el canal del parto.
En muchas ocasiones ocurre un proceso septicémico en el que el patógeno coloniza las articulaciones.
Cabe señalar que M. hyorhinis es más prevalente en la etapa de transición, ocasionando clínica al final de la transición.
En cuanto a problemas nerviosos, mencionar que pueden estar implicados agentes como S. suis, G. parasuis y Pestivirus K.
En el caso de Pestivirus K, los lechones se infectan en la gestación durante el desarrollo del sistema nervioso central, por lo que nacen positivos. La mortalidad de los lechones está ocasionada por la inadecuada ingestión de calostro y algunas veces se ha asociado de forma conjunta al síndrome splay-leg.

DESCÁRGALO EN PDF
Entre las técnicas diagnósticas disponibles para el abordaje de procesos articulares y nerviosos (Tabla 7), destaca el tipado bacteriano mediante qPCR.
S. suis o G. parasuis son agentes de gran interés epidemiológico y el serotipado permite establecer si hay diferentes serotipos involucrados, en función de la edad de los animales, diferentes explotaciones de una misma pirámide productiva, etc.
implicados
Técnicas S. suis G. parasuis M. hyorhinis
Cultivo y aislamiento bacteriano X X X
Pestivirus
Como conclusión, para poder establecer un diagnóstico definitivo en edad de lactación, se necesitará un estudio conjunto de las distintas técnicas laboratoriales partiendo de un diagnóstico diferencial que tenga en cuenta el cuadro clínico y lesional observado en los animales afectados.

Elena Goyena Salgado1,2, Emilio José Ruiz Fernández2, Manuel Guerra Rico2, Manuel Toledo Castillo3, José Manuel Pinto Carrasco4 y Rocío Garcia Espejo5
1Doctora en Medicina Veterinaria por la Universidad de Murcia.
2Veterinario de producción, Agropecuaria Casas Nuevas.
3Veterinario jefe de producción, Agropecuaria Casas Nuevas.
4Ingeniero Agrónomo, SAT Hnos. Chico.
5Asesora técnica veterinaria, Boehringer Ingelheim Animal Health España

La granja es positiva a PRRSV, pero
El destete de los lechones se realiza a los 28 días de lactación con una media de peso de

El número de lechones destetados por camada es de 12,5 lechones.


Gráfica 1. Media de lechones destetados por camada a la semana (Elaboración propia).
Se emplea el sistema de cubrir y soltar a los 3 días postcubrición.
Los datos de fertilidad y prolificidad son buenos, y este sistema de trabajo resulta más eficiente a la hora del manejo que el sistema convencional de soltar a los 28 días de la cubrición.
La granja se encuentra en una zona de alta densidad, pero debido a su ubicación, está alejada de cualquier vía de paso y de otras explotaciones ganaderas próximas.
Las nulíparas proceden de la multiplicadora propia de la empresa y son criadas en unas instalaciones que se encuentran fuera de la granja.
Es una pequeña recría en la que se aplica un programa vacunal para la adaptación sanitaria y productiva. Este movimiento se realiza con 8 semanas de estancia en la recría, donde son chequeadas antes de ser enviadas a la


El caso clínico comenzó con un incremento de los abortos a término que podría hacernos sospechar de un brote de PRRS, como se refleja en la Gráfica 2. Pero estos abortos no se producían en forma de tormenta, sino que todas las semanas se encontraba un incremento notable, es decir, un aumento en escalera.
Gráfica 2. Abortos semanales que se produjeron en la explotación (Elaboración propia).
Se comprobó que los abortos eran a término gracias al análisis del historial de la cerda abortada (días de gestación en el que se produjo el aborto) y la fertilidad.
Gráfica 3. Fertilidad semanal (Elaboración propia).
En la Gráfica 3 (5a semana) se muestra el momento de la caída de la fertilidad cuyo motivo se desconocía, ya que en la granja no se había comenzado a observar ninguna clínica, y, por lo tanto, se atribuyó a un problema de manejo.
Revisando el protocolo de manejo, se apreciaron algunos fallos que se comenzaron a corregir para volver a alcanzar los valores propios de la explotación. A pesar de ir mejorando, de nuevo se observó un descenso importante en la semana 11.


Estos valores pueden ser debidos a dos causas.
1. Un incremento de segundas cubriciones, es decir, cerdas que vienen de una repetición y, por lo tanto, son más problemáticas.
2. La existencia de cerdas que vienen de un aborto anterior. A este grupo de cerdas, aunque se haya dejado pasar un celo, se clasifican como cerdas problemáticas, y, por tanto, es normal que tengan más problemas para quedarse gestantes.

En la maternidad, se observó un incremento de lechones nacidos muertos por parto, aunque lo que era verdaderamente preocupante era la pérdida de la vitalidad de los lechones que nacían vivos.
Gráfica 4. Consecuencias de la infección respecto a la etapa de gestación (Elaboración propia).






Tal y como se muestra en la Gráfica 5, los nacidos muertos por semana aumentaban en las semanas 9, 10 y 11 y posteriormente volvían a los niveles normales de la explotación.

La granja cuenta con un programa de monitorización que consiste en la recogida semanal de trozos de lenguas de los lechones nacidos muertos, diferenciado siempre las lenguas que proceden de cerdas primíparas de las procedentes de lechones de cerdas multíparas.
La analítica solicitada es un pool de PCR para la detección de PRRSV y otro de Circovirus tipo 2 (PCV-2).
Gráfica 5. Lechones nacidos muertos por semana (Elaboración propia).
Con respecto a los lechones momificados, aunque en la Gráfica 6 se observa un incremento importante en la semana 11, no hubo una tendencia clara con respecto a este parámetro.
Hace tiempo, el seguimiento de la cadena de infección-prevención demostró que la vacunación de las reproductoras frente a PCV-2 (vacuna de subunidades, registrada) permite controlar la transmisión vertical y horizontal del virus.
Minimizar la exposición y maximizar la inmunidad
Transmisión horizontal
Fuente de nulíparas Recría de reproductoras Granjas de madres
Manejo de la transmisiñon vertical
Gráfica 6. Lechones nacidos momificados por semana (Elaboración propia).

Transmisión vertical
Lechones destetados Engorde Matadero
Minimizar la exposición y maximizar la inmunidad
Transmisión horizontal
Gráfica 7. Cadena de infección – Cadena de prevención de PCV-2 en pirámides de producción porcina.
Para nuestra sorpresa, las analíticas revelaron que todos los pools de las lenguas eran negativas a PCV-2 y PRRSV, pero positivas a Circovirus tipo 3 (PCV-3) (Tabla 1).
No Tubo (Individual) PCR PRRSV PCR PCV-2 PCR PCV-3
1 - - Ct 13 (+)


Otros procesos que entraron en el diagnóstico diferencial fueron:
Parvovirus porcino: la aparición de lechones momificados podría atribuirse a un proceso de parvovirosis, pero en este caso, no eran de distintos tamaños, sino que eran momificados a término y lechones nacidos débiles.
Se podría argumentar que estos resultados no explicaban los abortos ni la falta de vitalidad de los lechones nacidos vivos.
Sin embargo, la vitalidad de los lechones condiciona en gran medida su comportamiento productivo en las siguientes fases, ya que determina el grado de encalostramiento, y, por tanto, su capacidad de respuesta inmunitaria frente a las infecciones.
Estos lechones tienen dificultad para levantarse y amamantarse. Así, cuando la pérdida de vitalidad es muy evidente provoca un aumento de la mortalidad.
Por ello, se analizaron también los pulmones de los lechones que estaban naciendo con poca vitalidad, obteniéndose resultados similares (Tabla 2).
No Tubo (Individual) PCR PRRSV PCR PCV-2 PCR PCV-3
1 - - Ct 9 (+)
2 - - Ct 11 (+)
3 - - Ct 12 (+)
PCV-2: en la granja se vacunan a las reproductoras en sábana con una vacuna de subunidades para impedir la transmisión horizontal y reducir la vertical, y, por tanto, evitar los problemas de vitalidad que pueden ocasionar las viremias.
PRRSV: el caso descrito podría ser compatible con PRRS, aunque la sintomatología era muy limitada en el tiempo y en la intensidad.
Leptospirosis: esta enfermedad bacteriana puede ocasionar abortos al final de gestación, incremento de momificados y nacimiento de lechones débiles no viables.
Los resultados de los análisis laboratoriales y la observación de partos con lechones que tardaban mucho en levantarse e ir a tetar, con orejas agrandadas y pegadas en la parte posterior indujeron a pensar que podría estar involucrado el PCV-3.
Actualmente, diferentes estudios relacionan la presencia de PCV-3 con síntomas clínicos en lechones recién nacidos y con problemas reproductivos, como abortos.
Tabla 1. Resultados laboratoriales de los exudados obtenidos a partir de lenguas de los lechones nacidos muertos. Tabla 2. Resultados laboratoriales de los exudados obtenidos a partir de pulmones de los lechones nacidos muertos.Estos estudios también señalan que, dado que PCV-3 puede estar presente en animales sanos, para llegar a establecer un buen diagnóstico, hay que relacionar su presencia con la aparición de síntomas clínicos y lesiones en los lechones, y realizar pruebas de laboratorio como la hibridación in situ o técnicas de inmunohistoquímica.
Independientemente de las pérdidas productivas asociadas al incremento de abortos y nacidos muertos, lo más preocupante de las infecciones por PCV-3 es la pérdida de vitalidad de los lechones, dado que ello ocasiona que no tengan un buen desarrollo productivo a lo largo del resto de su vida productiva.
De acuerdo con la bibliografía existente, parece claro que:
No existe protección cruzada entre el PCV-2 y PCV-3.
La clínica que se describe se asocia bastante a la observada a nivel práctico en la granja, con incremento de abortos y lechones momificados, y una fuerte reducción de la vitalidad de los lechones nacidos vivos.
En este caso, la viremia no persistió en la granja, sino que a partir de las 4-6 semanas se dejaban de encontrar lechones con falta de vitalidad, hecho que coincidía con un descenso en los resultados positivos a PCR hasta obtener resultados negativos frente a PCV-3 (Tabla 3).

Es necesario realizar un buen diagnóstico diferencial con procesos que producen síntomas similares, no debiendo descartar al PCV-3 como agente involucrado en cuadros que cursen con abortos y lechones nacidos débiles.
Debido a la corta duración del proceso, el número de lechones afectados fue limitado, y, por tanto, la pérdida de vitalidad y la falta de un encalostramiento efectivo no tuvieron un gran impacto en la productividad de la granja.
La presencia de coinfecciones es muy importante en el desarrollo de los cuadros reproductivos, y hay que realizar más estudios para comprobar el peso específico que puede tener el PCV-3 en estos casos.
El nacimiento de lechones débiles puede deberse a numerosos factores y, a falta de más estudios, es posible que el PCV-3 tenga un papel secundario en este caso.
Tabla 3. Resultados laboratoriales de los exudados obtenidos a partir de lenguas de los lechones nacidos muertos a partir de las 4-6 semanas.Míriam Cerrillo, Miguel Moreno, Laura Burgos, Joan Noguerol y August Bonmatí IRTA, Sostenibilidad en Biosistemas, Caldes de Montbui, Barcelona
EL ALMACENAJE DE DEYECCIONES GANADERAS, EMISIONES Y LAS MEJORES TÉCNICA DISPONIBLES
El almacenaje de las deyecciones ganaderas en balsas en el exterior conlleva varios impactos al medioambiente que son necesarios mitigar.
En primer lugar, durante este almacenaje parte del amonio que contienen las deyecciones es liberado en forma de amoniaco a la atmósfera.
Este compuesto es responsable de la formación de aerosoles perjudiciales para la salud en la atmósfera, así como de la generación de emisiones secundarias de óxido nitroso (N₂O), un gas de efecto invernadero.
En segundo lugar, se emite metano (CH₄), un gas con un poder de efecto invernadero 80 veces superior al del dióxido de carbono (CO₂).



El Decreto 153/2019 de gestión de la fertilización y de las deyecciones ganaderas y el Real Decreto 306/2020, de ordenación de las explotaciones porcinas establecen nuevas obligaciones en el manejo de las deyecciones que implican un cambio en el actual modelo de la gestión de éstas.

Por ejemplo, se deben reducir un 40% las emisiones en balsas en explotaciones de ganado porcino existentes con capacidad productiva superior a 120 UGM (1.000 plazas de cerdos en cebo).
Por otra parte, la Directiva de Techos y la aplicación de las Mejores Técnicas Disponibles (MTD) son normas que condicionan el manejo de las deyecciones en granja y de la fertilización en campo.
Las MTD son un compendio de medidas compatibles y acumulables entre sí previstas para aplicar en granja para la reducción de las emisiones.
La acidificación de purines consiste en la reducción de su pH mediante la adición de un ácido (ácido sulfúrico generalmente) hasta un valor aconsejable alrededor de pH 5,5.




Actualmente, las MTD abarcan el ámbito de las explotaciones ganaderas en el manejo de las deyecciones hasta su aplicación en campo.
La MTD número 16, establecida en la Decisión de Ejecución (UE) 2017/302 de la Comisión Europea para la reducción de las emisiones generadas por el almacenamiento de purines, recoge las posibles actuaciones a llevar a cabo para reducir las emisiones de amoniaco a la atmósfera procedentes del almacenamiento de purines, entre las que se encuentran:
El correcto diseño de las balsas o depósitos de almacenamiento.
La cubrición de balsas con cubiertas rígidas, flexibles o flotantes.
La acidificación.

De esta manera, se favorece la conversión del amoniaco (NH3), que es un gas y puede ser liberado fácilmente a la atmosfera, en amonio (NH4+), que permanece en disolución en el purín.

En este equilibrio químico entre el amonio y el amoniaco, la temperatura también tiene un papel determinante, favoreciéndose la formación y volatilización del amoniaco a altas temperaturas.
La acidificación de purines durante el almacenamiento es una práctica extendida en otros países europeos, como Dinamarca, tanto en las granjas como en el campo en el momento de su aplicación, donde empezó a aplicarse en plantas a escala comercial en 2003 (Fangueiro et al., 2015)
En cambio, en España no es una técnica de gestión habitual y no se dispone de datos sobre su eficacia en la reducción de emisiones en las condiciones climáticas y de manejo específicas de las deyecciones ganaderas.
Los efectos de la acidificación de los purines sobre las emisiones han sido objeto de diversos estudios, describiéndose reducciones en la volatilización de amoníaco entre el 96% y 99% en el almacenaje de purines de vacuno (Petersen et al., 2012).

la volatilización del amoniaco durante y después de la aplicación en el campo, tal y como demostró un experimento en el que el amoniaco acumulado medido siete días después de la aplicación era aproximadamente un 67% más bajo para purines de cerdo acidificados en comparación con purines no tratados (Kai et al., 2008).

Debido al clima más cálido de la región mediterránea, es importante validar la efectividad de la técnica de acidificación de purines a diferentes temperaturas, además de hacerlo fuera de las condiciones controladas habituales en los laboratorios.
Por ello, en el marco del proyecto ACIDEMO*, el Instituto de Investigación y Tecnología Agroalimentarias (IRTA) está desarrollando un estudio mediante una planta piloto para acidificación de purín porcino situada en sus instalaciones de Caldes de Montbui (Barcelona).


La planta piloto de acidificación del proyecto ACIDEMO consta de 2 balsas de purín de 5 m³ cada una:
Balsa control: la primera balsa actúa como control.
Balsa acidificada: la segunda balsa dispone de un sistema de monitorización del pH y acidificación para mantener el purín a pH 5,5 (Imagen 1).
La acidificación se realiza en discontinuo en un tanque de 1 m³ con homogenización y dosificación lenta de ácido para reducir la generación de espumas durante el proceso.
En una primera etapa del proyecto, se ha realizado el seguimiento de las emisiones de las dos balsas de purín en periodo cálido, usando purín proveniente de una granja porcina de madres ubicada en Caldes de Montbui (Barcelona).
La composición inicial del purín se muestra

Imagen 1. Planta piloto de acidificación de purines del proyecto ACIDEMO.

Tabla 1. Caracterización inicial del purín.
El ensayo se ha realizado durante 80 días, entre junio y agosto de 2023.
Día 19 Día 28 Día 40
La acidificación de la balsa se llevó a cabo el día 19 de ensayo, manteniendo un pH promedio de 5,2 mediante reacidificación los días 28 y 40 de ensayo.

La temperatura media en el periodo que duró el ensayo fue de 25,5 °C, con un valor mínimo de 13 °C y un valor máximo de 41,6 °C (datos de la estación meteorológica de Caldes de Montbui, Portal de dades Obertes de la Generalitat).
La monitorización de los gases se ha realizado mediante una campana dinámica (tipo Lindvall, Imagen 2) conectada a un sensor de gases (GX-6000, RKI Analytical Instruments GmbH, Bad Homburg vor der Höhe, Alemania), además de la toma de muestras del purín de cada una de las balsas para realizar el seguimiento de la concentración de amonio

La acidificación inicial del purín de la balsa y mantenimiento a pH 5,5 durante el ensayo se realizó con un consumo de 3,7 kg/m³ de ácido sulfúrico (H₂SO₄, 95 %).
Los resultados obtenidos en la monitorización de la planta piloto de acidificación de purines durante la etapa de temperaturas cálidas han mostrado importantes diferencias entre las balsas control y acidificada.
 Imagen 2. Medición de las emisiones en la balsa acidificada mediante campana dinámica tipo Lindvall.
Imagen 2. Medición de las emisiones en la balsa acidificada mediante campana dinámica tipo Lindvall.
En 80 días, la concentración de nitrógeno total Kjeldahl (NTK) de la piscina control se redujo un 64%, pasando de 1.392 mg/kg a 504 mg/kg (Gráfica 1)
La balsa con purín acidificado finalizó el periodo de ensayo con una concentración de NTK de 1.974 mg/kg, aumentando ligeramente su valor inicial debido a la concentración por evaporación del agua.

Gráfica 1. Evolución de la concentración de nitrógeno N-NH4+ y NTK a lo largo del ensayo en la balsa control y en la balsa acidificada.
Balsa acidi cada 1,20
Acidi cación
Balsa control
Gráfica 2. Evolución de la tasa de emisión de nitrógeno a lo largo del ensayo en la balsa control y en la balsa acidificada.
Acidi cación
N-NH4+ Balsa acidi cada
NTK Balsa acidi cada
N-NH4+ Balsa control
NTK Balsa control
La tasa máxima de emisión de nitrógeno de la balsa control fue de 1,15 g/m²/h, coincidiendo con los valores de concentración de NTK más elevados. En las semanas posteriores, la tasa de emisión de nitrógeno se redujo a medida que disminuía la concentración de NTK del purín, llegando a un valor de 0,03 g/m²/h al finalizar los 80 días
La balsa con purín acidificado mostró una tasa de emisión nula en la mayoría de las mediciones, consiguiendo una reducción promedio del 97% respecto al control (Gráfica 2).
Solo al final del ensayo la balsa control mostró una tasa de emisión cercana a cero, con un valor de NTK 4 veces inferior al de la balsa acidificada.

La técnica de la acidificación en balsas de almacenamiento exterior con purín porcino de madres ha mostrado:
Su utilidad para la conservación del contenido de nitrógeno y el poder fertilizante de éste, mientras que en la balsa control se perdió el 64% del nitrógeno en 80 días.
En un período con temperaturas extremadamente cálidas, la tasa de emisión de nitrógeno fue nula en la balsa acidificada en la mayoría de los muestreos, mientras que tuvo un valor máximo de 1,15 g/m²/h en la balsa control, consiguiendo una reducción promedio del 97% de la emisión.
Sin embargo, se debe comprobar la eficacia de esta técnica con purines con mayor concentración de nitrógeno, como pueden ser los obtenidos en las granjas porcinas de cebo.
La evaluación de la técnica de la acidificación del purín en el almacenaje exterior en las condiciones climáticas específicas de la región mediterránea puede tener un efecto potenciador para su adopción por parte de los ganaderos.
En muchos casos, el hecho de no disponer de referencias a nivel local hace que no se adopte una determinada tecnología, por lo que este proyecto demostrativo ACIDEMO puede ser una excelente herramienta para obtener datos a nivel de la franja mediterránea que faciliten la adopción de la acidificación de purines como técnica de mitigación de emisiones.
El proyecto ACIDEMO seguirá en desarrollo hasta junio del 2024, y será una fuente valiosa de información para los ganaderos, no solo del efecto de la acidificación sobre las emisiones de amoniaco a la atmósfera, sino también de otros gases, como el metano, el H2S o el N2O.

Acidificación de deyecciones ganaderas en balsas de almacenamiento en clima mediterráneo: proyecto demostrativo ACIDEMO
DESCÁRGALO EN PDF



Después de 1 año de funcionamiento, los resultados avalan su transformación: I-FARMS vs 4 granjas convencionales.
ANTECEDENTES Y CONTEXTO
La granja I-Farms tiene una capacidad para 2.000 cerdos de engorde con dos naves de 60x14m que albergan 1.000 cerdos cada una.
Ventilación eficiente y sostenible
En esta granja se realizaron varias transformaciones, entre ellas, la instalación del sistema de ventilación Fancom que ha reemplazado la ventilación natural tradicional. Estos sistemas:
Permiten un control exhaustivo de la temperatura, humedad relativa y niveles de CO2 en las instalaciones.
Contribuyen significativamente a la eficiencia energética de la granja.
Aseguran un ambiente óptimo para los cerdos, lo que a su vez reduce el riesgo de enfermedades y estrés en los animales.
La ventilación forzada se ha logrado mediante la modificación de las 20 chimeneas existentes. Se reutilizaron seis chimeneas para instalar ventiladores de bajo consumo I-Fan 63 destinados a la ventilación mínima y otras seis chimeneas se adaptaron para albergar ventiladores “todo o nada” que solo se activan en verano para la ventilación máxima, lo que permite un control preciso del clima durante todo el año.

Se realizaron cambios en las ventanas de guillotina existentes, reemplazándolas por entradas de aire combinadas que aseguran una entrada de aire controlada y eficiente en las instalaciones.
Estas modificaciones no solo optimizan el clima interno, sino que también contribuyen a la sostenibilidad al reducir el consumo energético.

En lo que respecta a la alimentación, se han implementado sistemas de alimentación Roxell, que han reemplazado las típicas tolvas holandesas. Cada nave cuenta con 2 silos de 12 toneladas para el almacenamiento del pienso.
El transporte de alimento a las naves se realiza mediante el sistema de arrastre de cadena Discaflex, un método cerrado, fiable y duradero que no requiere, a diferencia de las espirales, la presencia de animales en los últimos corrales.

Las tolvas Roxell Blu’Hox se han adaptado a los corrales y separaciones de hormigón existentes, sustituyendo las tolvas holandesas, garantizando una óptima ingesta, sin desperdicio de comida ni agua, y las mejores conversiones.


Un componente crucial de esta granja inteligente es el ordenador Lumina 17 de Fancom que permite un control integral y preciso de todos los parámetros (control de ventilación, alimentación, calefacción, etc.) fundamental para el crecimiento y bienestar de los animales.

Los resultados de la Granja Inteligente I-Farms son extraordinarios en comparación con 4 granjas convencionales. I-Farms ha logrado:
Reducir el índice de conversión.
Minimizar las bajas.
Incrementar la ganancia de peso.
Reducir los días de engorde.
Esto se traduce en un aumento significativo de la PRODUCTIVIDAD y la EFICIENCIA.
Además de su desempeño sobresaliente, I-Farms destaca por su compromiso con la sostenibilidad.
La instalación utiliza equipos de bajo consumo eficientes y aprovecha la energía renovable a través de placas fotovoltaicas. También se ha reducido significativamente la producción de purines y las emisiones de CO2 y Amoniaco.
En resumen, la Granja Inteligente I-Farms de New Farms representa un paso audaz hacia el futuro de la cría de cerdos de engorde. Su enfoque en la eficiencia, el bienestar animal y la sostenibilidad demuestra cómo la tecnología puede transformar una explotación porcina tradicional en un modelo a seguir para la industria.
Porcentaje
La granja I-Farms ha tenido un 3,15% de bajas, lo que equivale a 63 bajas, mientras que la media de las 4 granjas convencionales (tradicionales) ha sido del 5,45%, lo que equivale a 109 bajas. Por tanto, en la granja I-Farms hubo 46 muertes menos por ciclo (-2,29% de diferencia).
Cada punto porcentual de aumento de la mortalidad supone un 0,7% de aumento en el coste final (según datos de Ceva Santé Animale, empresa líder en salud animal). Traducido en costes:
El coste de una baja supone aproximadamente un 70% del coste total de un animal salido de engorde.
Asumiendo un precio de 15€/cerdo sacado, esto corresponde a 690€ por ciclo de engorde (15€ x 46 animales muertos menos). Si suponemos unos 2,4 ciclos por año, esto supone unos 1.656€ menos por año.
El índice de conversión de I-Farms es el mejor de todas las granjas, suponiendo menos consumo de pienso para llegar al peso deseado, es decir, consumiendo menos pienso para llegar a un mayor peso ganado (95,407kg).
Esto supone:
95,407 kg x 2,252 = 214,856 kg en la granja I-Farms
en comparación con las naves tradicionales
94,186 kg x 2,389 = 225,010 kg
Ganancia de peso y días de engorde (en las instalaciones)
Peso entrada medio: 17,013kg
Peso de salida: 112,420kg
Peso ganado: 95,407kg
De las 5 granjas, I-Farms es la granja con mejor ganancia de peso de los animales y la de menos días de engorde. Con una ganancia de 95,407 kg y unos 149 días de engorde.
Los menores días de engorde suponen engordar antes los animales con un peso ganado mayor.
Disminuir el IC en granja I-Farms ha permitido una reducción de 10 kg de pienso consumido/animal (225,010214,856 = 10,154 kg), lo que, multiplicado por 2.000 animales, supone un ahorro de 20.308 kg de pienso por engordada.
Asumiendo un precio de 0,30€/kg de pienso, el ahorro asciende a 6.092,40€/ciclo de engorde (0,30€ x 20.308 kg), lo que, con 2,4 ciclos por año, supone un ahorro anual de 14.621,76€.
Estos resultados nos muestran las diferencias entre una granja convencional tradicional y una granja con la tecnología más avanzada del mercado.
Impulsada por New Farms, esta instalación ha evolucionado desde ser una explotación porcina tradicional hasta el concepto de granja inteligente, con un enfoque claro en la eficiencia, la sostenibilidad, el control integral, la óptima gestión, los mejores resultados, el bienestar animal, y la reducción de costes de producción y de emisiones.

El sello 100% Raza Autóctona fue creado hace diez años por el Ministerio de Agricultura, Pesca y Alimentación para dar respuesta a las necesidades de las pequeñas producciones autóctonas en el marco del programa nacional de conservación, mejora y fomento de las razas ganaderas.
Mª Cruz Castro PumaresLas razas autóctonas son parte del patrimonio genético que garantiza la protección de la biodiversidad ganadera, pero también constituyen parte del acervo cultural y de tradiciones mantenidas por nuestros pueblos durante generaciones.
No cabe duda de que sus índices productivos no sobresalen por arrojar rendimientos espectaculares, pero no es menos cierto que cuentan con la ventaja de un carácter rústico y adaptado al clima y a la orografía de las que son oriundas, lo que permite utilizar modelos de producción en régimen extensivo.
Sus producciones no destacan por su cantidad sino por su calidad, junto con las que aportan, de forma habitual, otros beneficios colaterales:
Realizan un aprovechamiento óptimo de los recursos del entorno, contribuyendo al cuidado y conservación del medio.
Estimulan la actividad económica en las zonas rurales, mitigando el abandono de los pueblos.
Todo ello justifica los esfuerzos por fomentar la permanencia de estas razas en nuestro horizonte, un propósito para el que son puntos de apoyo fundamentales:
Favorecer el aumento de ganaderías dedicadas a la cría de estas razas.
Estimular la demanda y consumo de sus productos.
En este escenario, el distintivo 100% tiene mucho que aportar, puesto que, con el etiquetado se identifican los productos que provienen de las razas ganaderas propias de nuestra tierra, diferenciándolos de los demás e incrementando su competitividad en el mercado.
De esta forma, se proporciona mayor visibilidad a estos productos ante los consumidores, junto con una información de procedencia atractiva para aquellos que además valoran otros criterios como la producción natural, respetuosa con el medioambiente, con el bienestar animal y afín al comercio de proximidad. Premisas que, potencialmente, pueden incrementar la demanda y promover la producción, elevando los censos de animales y el número de granjas.
En Galicia, la raza Porco Celta, autóctona y en riesgo de desaparición, se ha diferenciado en los últimos tiempos por ser una buena alternativa para el aprovechamiento de terrenos en desuso y para mantener los bosques y montes limpios de maleza.
Se trata de una forma eficiente de contribuir a la lucha contra los incendios forestales, al tiempo que se mantiene la actividad en las aldeas y se perpetúa la gastronomía tradicional típica en torno a los embutidos, salados y otros elaborados derivados del cerdo.
¿Cuál es la utilidad del Logotipo Raza
Autóctona 100% Porco Celta?
El Logotipo Raza Autóctona 100% pone en valor todas las bondades de los productos del Porco Celta en el etiquetado que llega a manos del consumidor final. Así, en la pequeña imagen del logotipo se traduce y concentra la información de origen y cría tradicional.
La Asociación de Criadores de la Raza

Porcina Celta (ASOPORCEL) solicitó el uso del sello Raza Autóctona 100% en el año 2016. Para ello, desarrolló un Pliego de Condiciones de Uso del Logotipo “Raza Autóctona” en los productos de la especie porcina de raza Porco Celta según lo establecido en el Real Decreto 505/2013, de 28 de junio, por el que se regula el uso del logotipo “Raza Autóctona” en los productos de origen animal.
ACCEDER AL Pliego de condiciones para el uso del logotipo “raza autóctona” en los productos de la especie porcina de raza Porco Celta

El 4 de abril de 2016, la Dirección General de Producciones y Mercados Agrarios, del Ministerio de Agricultura, dictó una resolución aprobatoria y la asociación de criadores se convirtió en cesionaria del uso del Logotipo Raza
Autóctona 100% Porco Celta.
A partir de ese momento, comenzó un exhaustivo trabajo de verificación en todas las fases de producción mediante la implementación de un sistema propio de autocontrol con el que poder garantizar la procedencia y autenticidad del producto final comercializado.
¿Cuál es el ámbito de aplicación del Logotipo Raza Autóctona 100% Porco Celta?
El conjunto de condiciones que regulan el uso de este sello en los productos procedentes de la raza Porco Celta tiene su ámbito de aplicación en todas las fases de la cadena (producción primaria, transformación y comercialización).
De esta manera, están sometidas a control:
Las granjas de nacimiento, cría y cebado de los animales.
Las instalaciones donde se realiza el sacrificio de los animales.
Las instalaciones posteriores en las que se lleve a cabo el despiece, elaborado y envasado de la carne y productos derivados.
Los puntos de venta donde se comercializan los productos, incluidos los locales de restauración que los sirvan.
Solo están legitimados para el uso del sello aquellas personas y/o entidades, previamente autorizadas por ASOPORCEL e inscritas en el registro de operadores creado al efecto, cuyos integrantes y sus contactos permanecen a disposición pública y actualizados en la página web de la asociación (www.asoporcel.es)
ACCEDER A www.asoporcel.es

¿Qué productos pueden llevar el Logotipo Raza Autóctona 100% Porco Celta?
Definidos el ámbito de aplicación del sello y los operadores legitimados para su uso, era necesario definir los productos a los que resulta aplicable.
El sello se empleará de forma exhaustiva y rigurosa en canales, despieces, productos elaborados y/o precocinados que procedan de animales inscritos en el libro genealógico de la raza Porco Celta y que se clasifican de la siguiente manera:
Lechón: animal desde nacimiento hasta el destete (mínimo 21 días – máximo 90 días).
Cochinillo destetado: animal no lactante hasta las 16 semanas de edad.
Cebo: animal desde las 16 semanas de edad hasta un máximo de 18 meses.
Cerda mayor: cerda dedicada a la reproducción en algún momento de su vida.
¿Cómo se garantiza la autenticidad de los productos con el Logotipo Raza Autóctona 100% Porco Celta?
El siguiente paso consistió en definir el sistema de trazabilidad con el que poder garantizar la autenticidad del producto final. Este sistema de autocontrol ha de aplicarse en todas las fases de la cadena, aun cuando en el establecimiento existan otros sistemas de seguimiento.
Se inicia con la identificación de los animales en las granjas.
Los lechones nacidos se marcan con crotales auriculares que contienen un código único e individual, información que se incorpora en una leyenda visual y en el transpondedor electrónico que porta ese crotal.
Con este código se inscriben en el registro correspondiente del libro genealógico.

Las ganaderías de origen también han de cumplir la reglamentación del libro genealógico y el programa de cría de la raza, debiendo estar ubicadas en Galicia o en zonas limítrofes que considere oportunas la asociación, cumpliendo otros condicionantes generales referidos en el pliego sobre el modo de cría (alimentación, manejo, etc.).

Una vez finalizada la etapa de cebado, el sacrificio de los animales ha de realizarse en un matadero registrado como operador autorizado para el uso del sello.
Tras el sacrificio, las canales se certifican con el sello 100% mediante precintos de seguridad que se colocan en las cuatro extremidades y en las orejas.
Estos precintos incluyen la imagen del logotipo y están numerados correlativamente.



Las canales así certificadas salen de los mataderos con destino a las industrias elaboradoras, que también estarán registradas como operadores autorizados en el uso del sello.
En este momento, aquellas piezas enteras (jamones, paletas y cabezas) que únicamente se someten al proceso de salado y curación, ya conservan como etiquetado final el precinto colocado en el matadero.
Esta numeración permite identificar el animal concreto del que procede, así como su ganadería de origen y datos de sacrificio.
Los despieces restantes y otros elaborados, como los embutidos, se etiquetan con una pegatina que incluye la imagen del sello y una numeración correlativa.



El conjunto del sistema de seguimiento de trazabilidad se apoya en registros documentales en todas las fases de la cadena. Así, las ganaderías de origen tienen que cumplimentar todos los impresos con los que se comunican nacimientos, altas y bajas en sus granjas para mantener el libro genealógico actualizado.
Aquellos animales que se transportan con destino a matadero tienen que ir acompañados de un documento de expedición de productos de 100% raza autóctona en el que el ganadero propietario consigna:
La fecha de traslado.
El número de animales que compone el lote.
Las identificaciones individuales de los animales.
El establecimiento de destino.
De igual manera, las canales salen de los mataderos acompañadas de otro documento 100% raza autóctona donde se consigna:
Fecha y lugar de sacrificio.
Ganadería de procedencia.
Industria elaboradora de destino.
Relación de los números de canal del lote con su correspondencia con el número del crotal de identificación del animal, peso y la numeración de los precintos que se le colocan en cada extremidad y cada oreja.
Finalmente, la industria elaboradora que recepciona estas canales cumplimenta un libro de trazabilidad de todos los productos que obtiene a partir de un mismo lote de sacrificio, así como de todas las piezas y envases etiquetados con el sello 100%.

ASOPORCEL, como titular del pliego, ha de velar por la correcta utilización del mismo, por lo que verifica el cumplimiento de este sistema de trazabilidad mediante inspecciones periódicas semestrales en los operadores autorizados de todas las fases de la cadena de producción.
En estas inspecciones se examina la identificación de los animales, el etiquetado de los productos y los registros documentales, pudiendo apoyarse en técnicas laboratoriales de análisis genéticos para realizar las oportunas comprobaciones.
Para completar el pliego de condiciones se estableció un régimen disciplinario en el que se relacionan las posibles no conformidades (de tipo administrativo, por incumplimiento del pliego o por uso indebido del sello) que se sancionarán en función de la gravedad de las infracciones, desde el apercibimiento hasta la suspensión temporal o definitiva del uso del logotipo.
Tras casi ocho años de funcionamiento del sistema, se encuentran registrados y autorizados como operadores:
107 granjas
13 industrias elaboradoras y comercializadoras
26 mataderos y salas de despiece
55 empresas comercializadoras (tiendas, carnicerías, restaurantes…)
La evolución de sacrificios a lo largo de estos años ha ido en aumento desde 2016 (Gráfica 1), lo que pone de manifiesto la importancia de apostar por la protección de nuestras razas autóctonas a través de medidas que ponen en valor sus productos con una calidad diferenciada.
Gráfica 1. Número de cerdos sacrificados portadores del Logotipo Raza Autóctona 100% Porco Celta entre el 2016 y el 2022.
Manuel Guerra y Emilio Ruiz
Departamento de Producciones de Agropecuaria Casas Nuevas

El hígado es un órgano esencial en el metabolismo de los animales, con una amplia gama de funciones críticas para la vida. Cualquier deterioro en su funcionalidad afectará a más de sus 500 funciones vitales, así como a la de otros órganos en los que tiene repercusión.
En la ganadería porcina intensiva, donde se buscan altos índices de producción, el flujo de nutrientes es intenso, con un equilibrio constante entre procesos anabólicos y catabólicos en proteínas, lípidos e hidratos de carbono, lo que redunda en una mayor necesidad de detoxificación.
El hígado juega un papel fundamental en este contexto y debe recibir especial atención para garantizar que las cerdas puedan expresar su potencial genético de manera óptima.
En cerdas reproductoras, los periodos más sensibles van desde el periparto a la lactación, siendo más evidentes en hembras hiperprolíficas.
A lo largo de la vida de la cerda en la granja, el hígado va acumulando afecciones que presentan curso crónico y que disminuirán la funcionalidad del órgano, repercutiendo en la salud y bienestar de los animales, así como en la rentabilidad de la explotación.
La condición corporal y el espesor de grasa dorsal (EGD) al final de la lactación son cruciales para que la cerda pueda salir en celo y para lograr un rendimiento reproductivo óptimo.
La mejora del metabolismo hepático reduce la pérdida de reservas y ayuda a mantener el intervalo destete cubrición óptimo.
Una estrategia para ayudar al hígado de las cerdas es el uso de potenciadores de la función hepática, en este caso se utilizó Igusafe WS.
Se trata de una fórmula única que combina extractos de plantas con propiedades antiinflamatorias, antioxidantes, coleréticas y colagogas. Esta combinación está diseñada para proteger y estimular las funciones del hígado, al mismo tiempo que actúa como un potente regenerador de los hepatocitos.
Durante el periparto, el hígado está en riesgo debido a la disminución del consumo de pienso, lo que resulta en un balance energético negativo y en la movilización de grasa hacia el hígado para obtener energía.
En lactación, la cerda experimenta un elevado esfuerzo metabólico, ya que, aunque su consumo de pienso aumenta, también lo hace la demanda energética necesaria para amamantar a un gran número de lechones. Esto sobrecarga el hígado, que debe ocuparse de:
La movilización de grasas.
El procesamiento de nutrientes.
La eliminación de productos no deseados.
Además, el hígado debe sintetizar algunos componentes de la leche por lo que, si su actividad se ve comprometida, repercutirá negativamente en la viabilidad y crecimiento de los lechones.
Con la finalidad de mostrar los beneficios del uso de un potenciador de la función hepática, presentamos en este artículo los resultados de un estudio reciente sobre el impacto de Igusafe WS en cerdas en lactación.
El objetivo de este ensayo consistió en determinar los efectos de Igusafe WS en el rendimiento de cerdas en lactación a través de:
La evaluación de la condición corporal antes del parto y al destete.
El seguimiento de los pesos de los lechones al nacimiento, al destete y la ganancia de peso.
La prueba se llevó a cabo en las instalaciones de Agropecuaria Casas Nuevas SA, Murcia, de mayo a agosto de 2023.
El diseño experimental contó con un total de 144 cerdas gestantes, de genética Topigs TN70 con diferentes ciclos reproductivos (1, 2, 3, 4 y ≥5). Estas cerdas se distribuyeron equitativamente en dos grupos de igual tamaño, con 72 cerdas en cada grupo.
Grupo control: dieta comercial sin administración del producto.
Grupo Igusafe WS: dieta comercial + Igusafe WS, administrado a través del agua de bebida a una dosis de 250 g/1.000 L.
Grupos Periparto (7 días antes del parto)
Lactancia (desde el parto hasta el destete)
Control 0 0
Igusafe WS 250 g/1.000 litros 250 g/1.000 litros
Tabla 1. Distribución de grupos y dietas
La fórmula del pienso es propiedad intelectual de la granja. Los análisis calculados fueron para una dieta de lactación estándar.
Tabla 2. Análisis fisicoquímico de la dieta durante el estudio.
A lo largo del estudio, se recopiló información sobre los siguientes parámetros:
Condición corporal inicial (periparto) y final (al destete) de las cerdas, utilizando una escala de condición corporal que abarcó desde:
1) 2) 3) 4) 5)
Muy delgada
Delgada
Adecuada
Con sobrepeso
Obesa
Tamaño medio de la camada (número de lechones nacidos vivos por cerda).
Peso medio de la camada al nacimiento y al destete (kg/lechón).
Ganancia media diaria de los lechones (GMD).
Los datos analizados se estudiaron mediante un diseño completamente al azar con 2 grupos (control vs. Igusafe WS), utilizando el procedimiento MIXED de SAS (SAS Inst., 2004).
Cada tratamiento se replicó 72 veces y la unidad experimental fue la cerda.
Se estudió el efecto del grupo (control vs. Igusafe WS) y el número de ciclo reproductivo por cerda por separado, utilizando el procedimiento MIXED de SAS (SAS Inst., 2004).
Cuando se detectaron diferencias significativas entre tratamientos, las medias se separaron mediante un test-Tukey. Todas las diferencias se consideraron estadísticamente significativas a P<0,05 y los valores de P entre 0,05 y 0,15 se consideraron con tendencia a la significación estadística.
PESO MEDIO (AL NACIMIENTO Y AL DESTETE) Y GMD DE LOS LECHONES
Los lechones del grupo Igusafe WS tuvieron un peso medio al nacimiento más bajo (P<0,024) en comparación con el grupo control (-7,1%). Sin embargo, al destete, los lechones del grupo Igusafe WS mostraron un peso medio al destete significativamente mayor (P<0,001) en comparación con el grupo control (+9,2%).
La GMD de los lechones del grupo Igusafe WS fue significativamente mayor (P < 0,001) que la del grupo control (+14,75%).
Estos resultados sugieren que, a pesar de su menor peso al nacimiento, los lechones del grupo Igusafe WS experimentaron un mayor crecimiento durante la lactación.
Tabla 3. Efecto de Igusafe WS en cerdas lactantes y lechones.
La Gráfica 1 muestra las diferencias en la condición corporal de los grupos de cerdas al inicio de la prueba (periparto) en relación con el número de ciclos reproductivos.
CONDICIÓN CORPORAL INICIAL (PERIPARTO) Y FINAL (AL DESTETE) DE LAS CERDAS
Antes del parto no se observaron diferencias significativas en la condición corporal entre los dos grupos. Sin embargo, al destete, las cerdas que recibieron Igusafe WS mostraron una mejora significativa (P<0,001) en su condición corporal (+23,5%) en comparación con el grupo control (Tabla 3).
Esto indica que el grupo Igusafe WS tuvo menor pérdida de la condición corporal durante la lactación.
Se puede observar que, al analizar la condición corporal periparto en los distintos ciclos, no había diferencias significativas entre los grupos a excepción del ciclo 2, donde el grupo control presentó una condición corporal mejor en comparación con la del grupo Igusafe WS.
Gráfica 1. Condición corporal inicial de cerdas de acuerdo con su ciclo reproductivo.
La Gráfica 2 muestra las diferencias en la condición corporal de las cerdas al destete entre aquellas que recibieron el tratamiento con Igusafe WS y las del grupo control en relación con el número de ciclos reproductivos.
***:
Gráfica 2. Condición corporal al destete de cerdas de acuerdo a su ciclo reproductivo
Los resultados indican que las cerdas que recibieron Igusafe WS presentaron una condición corporal más constante y homogénea, independientemente del número de ciclos reproductivos en comparación con las del grupo control que presentaron una mayor variabilidad en su condición corporal y esta aumentó con el número de ciclos reproductivos.
Además, dentro del grupo Igusafe WS, se observó una mejora estadísticamente significativa de la condición corporal de las cerdas de segundo y quinto parto (pese a que las cerdas del grupo Igusafe WS de segundo parto tenían una peor condición corporal periparto que las del grupo control). Las cerdas de tercer y cuarto ciclo mostraron una tendencia a tener mejor condición corporal al destete cuando fueron tratadas con Igusafe WS
La Gráfica 3 muestra que, independientemente del número de ciclos reproductivos, en comparación con el grupo control, con Igusafe WS se consigue:
Mayor GMD de los lechones durante la lactación.
Mayor homogeneidad de la camada.
La importancia de mantener la salud hepática en las cerdas reproductoras DESCÁRGALO EN PDF
Gráfica 3. GMD de los lechones durante la lactancia en función del ciclo reproductivo de la cerda.
Los resultados indican que la administración de Igusafe WS tiende a tener un efecto notable en la condición corporal de las cerdas al destete.
En particular, las cerdas que recibieron Igusafe WS presentaron una condición corporal más constante y homogénea, independientemente del número de ciclos reproductivos. Por otro lado, las cerdas que no recibieron el producto mostraron una mayor variabilidad en su condición corporal y esta variación aumentó a medida que el número de ciclos reproductivos aumentaba.
En general, los resultados indican que la administración de Igusafe WS durante el periparto y la lactación es beneficiosa para mantener la condición corporal de las cerdas y mejora la GMD de los lechones durante la lactación, obteniéndose un mayor peso al destete.
Esto ayudaría a tener más homogeneidad en las camadas y menos animales destetados con bajo peso, que se asocian a una mayor mortalidad, menor crecimiento y peor conversión.
Todo ello se traduce en una mayor eficiencia en la granja de reproductoras y en el cebo, preparando a las cerdas de manera más efectiva para el próximo ciclo reproductivo y promoviendo un crecimiento óptimo de los lechones.














